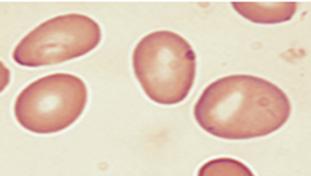

HEMATOLOGÍA
Jhon Ortiz




Anemia: se define como la disminución del nivel de hemoglobina por debajo de los valores normales según la edad y sexo. La OMS lo define de la siguiente manera:
También la OMS plantea realizar correcciones a los valores de hemoglobina dependiendo de ciertas condiciones como la altura por encima del nivel del mar en la cual vive la persona y/o el hábito tabáquico, de la siguiente manera:
Anisocitosis: es un término que define la presencia de alteraciones en el tamaño y volumen del hematíe de un paciente, este puede ser evaluado mediante la amplitud de distribución eritrocitaria (ADE), también llamado RDW (por las siglas en ingles). Los valores normales de ADE son entre 11 a 15%, será anisocitosis cuando sea mayor de 15%. Característicamente se presentan en las anemias carenciales.
Poiquilocitosis: Este término se usa cuando hay alteraciones en la forma de los hematíes, esto se hace manifiesto en la prueba de lámina periférica. Dependiendo de la forma que adopta el hematíe puede describirse diferentes tipos y además algunas formas son características de determinadas patologías. Por ejemplo:
Dacriocitos: en forma de lágrima. En mielofibrosis o mieloptisis.
Drepanocito: en forma de plátano. En anemia falciforme.
Acantocitos: en forma espiculada. En hepatopatías
Esquistocitos: hematíes fragmentados. En hemolisis intravascular.
Esferocitos: forma esférica de menor tamaño. Típico de la esferocitosis hereditaria.
Eliptocitos: forma elíptica. Típico de la eliptocitosis hereditaria.
- Estomatocitos: el hematíe presenta una depresión central en forma de boca. Típico de la estomatocitosis hereditaria.
- Rouleaux: hematíes agrupados en pila de monedas. En el mieloma múltiple.
- Equinocitos: en forma de espuelas, más cortas y regulares que las del esquistocito. En insuficiencia renal.
- Dianocitos: aumento del área clara central del hematíe. En talasemias y hemoglobinopatías C, también en anemia ferropénica severa.


Anisocitosis es la variabilidad en el tamaño y la poiquilocitosis es la variabilidad en la forma del hematíe.
(ESSALUD 2012)





De la misma manera, en lámina periférica también se puede observar las llamadas inclusiones eritrocitarias las cuales también tienen correlación con ciertas patologías. Por ejemplo:

Punteado basófilo: grumos de color azul grisáceo en la tinción con Giemsa. Corresponden a ribosomas. En intoxicación por plomo (ESSALUD 2013)
Cuerpos de Heinz: gránulos eritrocitarios únicos y excéntricos. Resultado de la precipitación de las cadenas de hemoglobina.

corpúsculo de Howell-Jolly: corpúsculos redondeados de mayor tamaño únicos de color oscuro que corresponden a restos nucleares. En hipoesplenismo o esplenectomía.






Anillos de Cabot
Cuerpos de Pappenheimer

Existen diferentes maneras de clasificar a las anemias. Una de las más usadas es en base al volumen corpuscular medio (VCM), lo cual sería de la siguiente manera:
Volumen corpuscular medio (VCM)
VCM < 80fL
- Anemia ferropénica
- Anemia por intoxicación de Pb
- Talasemias
- Anemia sideroblástica
- Anemia por enfer medad crónica
VCM 80-100fL
- Anemia por enfer medad crónica

- Insuficiencia renal crónica
- Hemorragia aguda
- Hemolisis aguda
- Anemia aplásica
VCM > 100fL
Megaloblásticas
- Deficiencia de B9
- Deficiencia de B12
No megaloblásticas
- Alcoholismo
- Hepatopatías
- Hipotiroidismo
- Síndrome mielodisplásico (ESSALUD 2015)
Es una anemia que se desarrolla debido a la deficiencia de hierro en el organismo. Es el tipo de anemia más frecuente a nivel mundial .
Las causas de la deficiencia de hierro pueden clasificarse en cuatro grupos:
Por aumento de necesidades
– Menores de 2 años – Adolescencia
– Embarazo
– Lactancia materna
La deficiencia de hierro no se relaciona directamente con el alcoholismo.
Por disminución de la ingesta
– Trastornos de la alimentación
Desnutrición
– Niños que no inician ablactancia adecuada
Por disminución de la absorción
– Pacientes gastrectomizados – Gastritis atrófica
– Enfermedad celiaca
– Enfermedad inflamatoria intestinal
Consumo de antiácidos
Por aumento de las perdidas – Sangrado digestivo: Consumo de AINEs, cáncer de colon, cáncer gástrico, úlceras gástricas, parasitosis (por ejemplo, Trichuris trichiura) (ESSALUD 2007) –
Sangrado ginecológico: menorragias, hipermenorreas, metrorragias.
Genitourinarias: cálculos renales
La fisiopatología de la anemia ferropénica se divide en tres estadios: Depleción de depósitos: Esta fase consiste en la disminución de la cantidad de hierro en los depósitos, pero el desarrollo de eritrocitos aún es normal, porque el hierro aún es suficiente para mantener los compartimientos de transporte y funcional. No hay disminución de hierro sérico, pero sí de los depósitos como ferritina y hemosiderina. No hay síntomas de anemia. Eritropoyesis ferropénica: Aquí ya se agotan los compartimientos de depósito de hierro. Aún puede mantener la producción de eritrocitos, pero utilizando el hierro del compartimiento de
La causa más frecuente de anemia ferropénica en el adulto varón es pérdida crónica de pequeñas cantidades de sangre
transporte. Ya comienza a disminuir el contenido de hemoglobina de los reticulocitos, es por eso el nombre eritropoyesis deficiente o ferropénica. Aún la hemoglobina es normal, aunque puede estar disminuyendo y aumentando el RDW. Ahora si el hierro sérico disminuye y el TIBC (capacidad de saturación de la transferrina) aumenta, también aumenta la protoporfirina libre (PEL), aumenta los receptores de transferrina (tratando de compensar la falta de hierro). Aún no hay síntomas de anemia. Anemia ferropénica establecida: Esta fase es la anemia franca, aquí ya hay disminución de hemoglobina y hematocrito, el hierro tanto de depósito como de transporte también siguen bajos. Al inicio hay eritrocitos pequeños con hemoglobina adecuada, pero al final ni siquiera estas células pequeñas pueden llenarse de hemoglobina, por lo tanto, están pequeñas y con poco color, ósea microcítica e hipocrómica. Aquí ya hay síntomas de anemia.
Depleción de hierro
Nivel normal de hierro Estadio 1 Estadio 2 Estadio 3
Depleción de los depósitos de hierro
Depleción del transporte de hierro
Depleción del funcional (anemia ferropénica)
Compartimiento de almacenamiento de hierro
Compartimiento de transporte de hierro
Compartimiento de hierro funcional Valores
Clínica

Palidez
Fatiga
Poca tolerancia al ejercicio
Disnea al esfuerzo
Angina
Vértigo
Glositis atrófica
Pica y ansiedad de comer hielo
Coiloniquia
Queilosis
Síndrome de piernas inquietas
Escleras azules
Síndrome de Plummer Vinson
Piel seca o áspera
Alopecia (rara)
Clorosis (extremadamente rara)
Hemoglobina baja
Reticulocitos disminuidos
VCM bajo
HCM bajo
CHCM bajo
RDW elevado
Ferritina disminuida (ESSALUD 2012, 2013)
La ferritina tiene una alta sensibilidad y especificidad para el diagnóstico de anemia ferropénica.
El hierro por vía oral es el tratamiento de elección de anemia ferropénica.
Los fitatos, oxalatos, taninos, calcio, fosfatos, antiácidos disminuyen la absorción de hierro.
Hierro sérico disminuido
TIBC aumentado
Saturación de transferrina disminuida
AMO: hierro en sideroblastos y macrófagos disminuidos. El estudio de médula ósea no está indicado para la sospecha de deficiencia de hierro no complicada. Puedes cursar con leucocitos normales y plaquetas aumentadas
Protoporfirina eritrocitaria libre aumentada
Lámina periférica de anemia ferropénica, las marcas verdes indican eritrocitos microcíticos e hipocrómicos

Etiológico: lo primera en el manejo es determinar la etiología y tratarla.
Hierro: puede brindarse por vía oral o por vía parenteral.
Vía oral: la dosis de tratamiento se basa en hierro elemental (ESSALUD 2014), para adultos 150 a 200 mg/día (ESSALUD 2007) y para niños 3 a 5 mg/kg/día, se sugiere tomarlo en ayunas y junto a vitamina C, de esa manera mejoraría la absorción.
La respuesta al tratamiento de hierro se puede medir con reticulocitos que inicia su aumento a los 2 a 3 días siendo más evidente entre los 5 a 10 días, la hemoglobina aumenta a las 2 a 3 semanas llegando a valores normales a los 2 meses; todo esto cuando se realiza un adecuado tratamiento. El tiempo es por 3 a 4 meses después que la hemoglobina se normalice, ya que esto serviría para llenar los depósitos
Vía parenteral: La vía parenteral incluye opciones como endovenoso, intramuscular o intradérmico, pero de los tres el único que se prefiere es el endovenoso. El cálculo del déficit de hierro (en mg) para aplicar por vía EV se determina con la fórmula de Ganzoni. Hay reacciones adversas que pueden ocurrir tanto alérgicas como no alérgicas. Podría usarse premedicación con corticoides.
Ecuación de Ganzoni: Peso x (Hb objetivo – Hb actual) x 2.4 + depósito

Peso: es el peso del paciente en kilos
Hb objetivo: para menores de 35 kilos usar 13 g/dl y para mayores de 35 kilos usar 15 g/dl
Las presentaciones de hierro por vía oral tendrán diferente concentración de hierro elemental:
- Sulfato ferroso tiene 20% de hierro elemental
- Gluconato ferroso tiene 12% de hierro elemental
- Fumarato ferroso tiene 33% de hierro elemental
Las reacciones adversas más frecuentes de la terapia con hierro por vía oral son las gastrointestinales como náuseas, vómitos, dolor abdominal.
Hb actual: es la hemoglobina del paciente en g/dl
Depósito: es 15mg/kg para menores de 35 kilos y 500 mg para mayores de 35 kilos
Presentaciones de hierro endovenoso: Hierro dextrano de bajo peso molecular

Carboximaltosa férrica
Gluconato férrico
Ferumoxytol
Isomaltoside de hierro
Sacarosa de hierro
Indicaciones para manejo con hierro endovenoso: Si el paciente no tolera los efectos adversos de la terapia vía oral
Si el paciente lo solicita
Perdida de sangre severa y en curso
Condiciones anatómicas que impidan el manejo por vía oral
Transfusión sanguínea: está indicada cuando la anemia es severa y genera compromiso hemodinámico.
Es la anemia que se desarrolla secundariamente a procesos o enfermedades sistémicas. Es la segunda anemia más frecuente a nivel mundial, pero la primera en pacientes hospitalizados. Su nombre ha sufrido actualización, ahora se le suele llamar “anemia inflamatoria”.
Como su nombre lo menciona esta anemia es debido a una inflamación crónica secundaria a diferentes procesos que pueden dividirse en tres tipos generales:
Enfermedades inflamatorias crónicas
Enfermedad inflamatoria intestinal
Artritis reumatoide
– Sarcoidosis
– LES
– Vasculitis
Infecciones crónicas
– Infecciones complicadas del tracto urinario, la piel o la estructura de la piel
– Endocarditis
– Infección por VIH
Osteomielitis – Neumonía
– Septicemia
– Tuberculosis
– Otras infecciones sistémicas bacterianas, parasitarias, virales y fúngicas
Neoplasias malignas
– Hematológicas
– Otras neoplasias
Otros: – ICC
– EPOC e hipertensión pulmonar
– Obesidad
Tabla 5. Etiología de la anemia por enfermedad crónica
Durante la inflamación los macrófagos liberan citocinas como IL-1 beta, TNF-alfa, IL-6. Las citocinas estimulan la producción de hepcidina a nivel hepático, la hepcidina se encarga de bloquear a la ferroportina que se encuentra en el enterocito, hepatocito y macrófagos, de esa manera impide la salida de hierro y lo acumula dentro de estas células; esto genera una disminución del hierro sérico (hipoferremia). Se piensa que esta respuesta de la hepcidina durante la inflamación será un mecanismo de defensa inespecífico contra las bacterias invasoras.
Durante la inflamación, la lactoferrina de los neutrófilos es liberada en el plasma, ahí rescata el riesgo disponible a expensas de la transferrina, ya que su avidez por el hierro es mayor que de la transferrina. Luego la transferrina se une a loa macrófagos y hepatocitos ya que estos tienen receptores de transferrina, mientras que los eritrocitos se ven privados de este hierro porque no tienen dichos receptores.
Durante la inflamación también aumenta la ferritina, esta ferritina en el plasma también unen parte del hierro. Y debido a que los eritrocitos en desarrollo no tienen receptores de ferritina, este hierro no está disponible para su incorporación en le hemoglobina.
También, las citocinas de la inflamación actúan en el riñón disminuyendo la producción de EPO a nivel de las células peritubulares intersticiales, y a la médula ósea impidiendo una adecuada eritropoyesis.
Infección, inflamación, malignidad

Diagnóstico
Clínica
IL - 6
IL-1b
Aumento del hierro de los macrófagos
Exportación deficiente de hierro

IL - 1B
TNF-a
Absorción deficiente de hierro
Tracto gastrointestinal
Producción inadecuada de eritropoyetina
Eritropoyesis reducida
Los pacientes suelen ser asintomáticos o con síntomas leves, cursando con anemia leve.
Exámenes
Hemoglobina disminuida levemente
Reticulocitos disminuidos
VCM normal (a veces disminuida)
En la anemia por enfermedad crónica, generalmente la clínica del paciente es por la enfermedad de fondo más que por la anemia.

HCM normal (a veces disminuida)
Ferritina normal o elevada
Hierro sérico disminuido
TIBC disminuido
Saturación de transferrina normal o disminuida
PEL elevado (no usado frecuentemente)
AMO: revela hipoproliferación de eritrocitos, abundante hierro en los macrófagos (tinción de azul de Prusia), este último no usado frecuentemente.
Los leucocitos y plaquetas pueden estar elevados, pero por la enfermedad de fondo.
El mejor tratamiento de la anemia por enfermedad crónica es el control eficaz o la eliminación de la enfermedad subyacente.
El manejo consiste en tratar en primer lugar la enfermedad de fondo, ya que con esto disminuiría la inflamación y por ende la anemia. A diferencia de la anemia ferropénica aquí no se suele dar hierro ya que no podría ser usado por el organismo, sino por el contrario generaría reacciones adversas.
La administración de EPO (eritropoyetina) puede corregir la anemia por inflamación crónica, pero debe administrarse hierro en forma simultánea, ya que el hierro del organismo esta secuestrado. La transfusión sanguínea también es otra opción. Estas opciones muchas veces no son usadas ya que la anemia generalmente es leve.
Es la anemia que se desarrolla debido a la deficiencia de la vitamina B12 o B9. La anemia megaloblástica tiene como razón principal la alteración de la síntesis de DNA. Recibe su nombre por la presencia de células muy grandes debido a una reducción en el número de divisiones celulares.
Anomalías gástricas
Autoanticuerpos contra el factor intrínseco o las células parietales gástricas (anemia perniciosa) (ESSALUD 2010)
Gastrectomía/cirugía bariátrica
Gastritis
Gastritis atrófica metaplasia autoinmune
Enfermedad del intestino delgado
Síndrome de malabsorción
Resección ileal (ESSALUD 2019) o bypass
Enfermedad inflamatoria intestinal (Ej., Enfermedad de Crohn)
Enfermedad celiaca
Crecimiento excesivo de bacterias
Bucle ciego
Páncreas
Insuficiencia pancreática
Dieta
Lactante amamantado de una madre con deficiencia de B12
Dieta vegana estricta
Dieta vegetariana en el embarazo
Agentes que bloquean o dificultan absorción
Neomicina
Biguanidas (Ej., Metformina)
Inhibidores de la bomba de protones (Ej., Omeprazol)
Antagonistas del receptor de histamina 2 (Ej., Cimetidina)
Gas de óxido nitroso usado para anestesia o de forma recreativa
Deficiencia hereditaria de trascobalamina II
El factor intrínseco es crucial para la absorción de vitamina B12.
El Diphyllobothrium latum es un parásito que absorbe vitamina B12 por lo que causa anemia megaloblástica. (ESSALUD 2006)
Deficiencia nutricional
Abuso de sustancias
Alcoholismo
Ingesta dietética deficiente Alimentos recocidos
Pacientes deprimidos
Hogares de ancianos
Malabsorción
Enfermedad celiaca
Enfermedad infamatoria intestinal
Enfermedad infiltrativa del intestino
Síndrome del intestino corto
Drogas
Metotrexato
Trimetoprima
Etanol
Fenitoína
Mayor demanda
Embrazo, lactancias
Hemolisis crónica
Dermatitis exfoliativa
Tanto la deficiencia de vitamina B9 y B12 alterarán la producción del nucleótido timidina para la síntesis de ADN. El efecto de la deficiencia de vitamina B9 es más directa y el de la deficiencia de vitamina B12 es más indirecta. Deficiencia de vitamina B9: impide la metilación de dUMP. Deficiencia de vitamina B12: impide la producción de THF a partir de 5-metiltetrahidrofolato. También ante la deficiencia de B9 y B12 hay acumulación de homocisteína. La alteración del ADN se detiene la división celular lo que resulta en la lisis celular o bien en la apoptosis; esto se verá más evidente en tejidos de alta demanda de recambio celular, como son la médula ósea dando no solo disminución de producción de eritrocitos, sino también de las demás células, también en lengua y en el tubo digestivo.
UMP (desoxiuridina)
En la anemia megaloblástica cursa con hemolisis intramedular, debido a que las células mueren durante la división en la médula ósea.
En la anemia megaloblástica hay alteración de la síntesis de DNA, pero la función del ARN no se ve afectada.
Sitio del efecto en la deficiencia de folato
Timidilato sintetasa
Timidina dATP
dGTP
dCTP
dTTP dUMP (desoxiuridilato monofosfatasa)
N5 N10 metileno FH4
dTMP (desoxitimidilato monofosfatasa)
FH2 (dihidrofolato)
DNA
Glicina
Serina
FH4 (tetrahidrofolato)
Reductasa del dihidrofolato
Metionina
Vitamina B12
Homocisteína
Sitio de atrapamiento de MTHF (N5-metil FH4)

N5 - metil FH4 (MTHF) (5-metiltetrahidrofolato)
Figura 7. Síntesis de DNA
Clínica
Anemia megaloblástica sin síntomas neurológicos piensa en deficiencia de vitamina B9, pero con síntomas neurológicos piensa en deficiencia de vitamina B12.
Tanto la deficiencia de vitamina B9 y B12 llevan a un síndrome megaloblástico, pero además cuando es una deficiencia de vitamina B12 se agrega clínica neurológica conocida como mielosis funicular.
Síndrome megaloblástico: Síntomas generales relacionados a anemia (cansancio, debilidad, disnea) y síntomas del aparato digestivo como glositis, gastritis, náuseas o estreñimiento.

Los síntomas psiquiátricos de la anemia megaloblástica son también llamados como la psicoanemia de Weil

La macrocitosis leve suele ser el signo más temprano de la anemia megaloblástica.
Mielosis funicular o degeneración combinada subaguda medular: estos incluyen pérdida de memoria, entumecimiento y hormigueo en los dedos de pies y manos, perdida del equilibrio y problemas al caminar por la pérdida de la sensibilidad vibratoria-posicional, también síntomas psiquiátricos como cambios de personalidad y psicosis. Todo esto por la desmielinización de las columnas blancas posteriores de la médula espinal y de nervios periféricos.
Exámenes (ESSALUD 2001)
Hemoglobina disminuida (suele ser muy baja al detectar la anemia megaloblástica)
Reticulocitos disminuidos
VCM aumentado
HCM suele ser normal
CHCM suele estar en rango de referencia
RDW aumentado
Lámina periférica: macrocitos ovalados, neutrófilos polisegmentados (más de 5 y aparece en las primeras etapas de la enfermedad) (ESSALUD 2006). También puede haber Dacriocitos, fragmentos de eritrocitos, microesferocitos, eritrocitos nucleados, cuerpos de Howell-Jolly, punteado basófilo y anillos de Cabot.
Bilirrubinas elevadas a predominio indirecto y elevación de LDH (debido a la hemolisis intramedular: eritropoyesis ineficaz)
AMO: sigue siendo la prueba confirmatoria de referencia para identificar el aspecto megaloblástico de los eritrocitos en desarrollo. En general, la médula ósea es hipercelular, sin embargo, la eritropoyesis es ineficaz y, a pesar del aumento de la producción de células en la médula ósea, la muerte de las células en la médula determina una pancitopenia periférica.
Vitamina B12
↓ : <200 pg/mL
↔ : 200-300 pg/mL
N : >300 pg/mL
Ac. fólico
↓ : <2 ng/mL
↔ : 2-4 ng/mL
N : > 4 ng/mL
Los leucocitos y plaquetas están disminuidas, junto a la anemia se denomina pancitopenia Dosaje de vitamina B9 y B12 Medición de ácido metilmalónico y homocisteína. Los dos están elevados en deficiencia de vitamina B12, pero en la deficiencia de vitamina B9 solo está elevado la homocisteína.
Test de Schilling: es una prueba que sirve para identificar la causa de la anemia megaloblástica por deficiencia de vitamina B12. Es un método isotópico complejo que determina la excreción urinaria de B12 tras la administración oral de la vitamina marcada con un radioisótopo. Primero se administra 1.000 mg de vitamina B12 por vía intramuscular con el fin de saturar los depósitos hepáticos, que facilitan de este modo que la vitamina absorbida se elimine por la orina. A continuación, se administra por vía oral una dosis de esta vitamina marcada con el radioisótopo, se recoge la orina durante 24 horas y se mide la cantidad del radioisótopo que contiene. En condiciones normales se eliminan por orina entre el 8% y el 30% de la dosis ingerida, por lo que una eliminación inferior al 7% se considera patológica. Luego, se sigue los pasos como el siguiente algoritmo.
Ingesta inadecuada B12
Origen no digestivo
Embarazo
Far macos
Hipotiroidismo
Enfer medad hematológica
Deficit B12 en suero
Negativa
Prueba de Schilling
Malabsorción B12
Negativa
Anemia per niciosa
Negativa
Sobrecrecimiento bacteriano
Schilling + factor intrinseco
Schilling + antibióticos
Positiva
Afectación ileal Sobrecrecimiento bacteriano Insuficiencia pancreática
Positiva
Afectación ileal Insuficiencia pancreática

Negativa
Schilling + enzimas pancreáticas
Insuficiencia pancreática
Positiva
Afectación ileal
Tratamiento de la causa subyacente.
La deficiencia de vitamina B12 puede tratarse con vitamina B12 oral o parenteral (ESSALUD 2019). Para los pacientes con deficiencia de vitamina B12 que tienen síntomas preocupantes (por ejemplo, anemia grave o sintomática, hallazgos neuropsiquiátricos), se sugiere vitamina B12 parenteral en lugar de oral. Esto asegura una rápida absorción y cumplimiento, aunque las mejoras en la anemia y los hallazgos neuropsiquiátricos pueden ser equivalentes a la administración ora.
La dosis es de 1000 mcg por inyección subcutánea o intramuscular profunda una vez a la semana durante un mes, seguida de 1000 mcg una vez al mes.
La vitamina B12 oral (o sublingual) 1000mcg al día son alternativas efectivas si la adherencia no es una preocupación. Si se usa vitamina B12 oral en individuos con absorción alterada, la dosis es de 1000 a 2000 mcg al día.
La deficiencia de vitamina B9 se trata con ácido fólico 1 a 5 mg/día y se pueden administrar por vía oral o parenteral.
La respuesta al tratamiento adecuado se evidencia por:
Disminución de bilirrubinas y LDH en 1 a 2 días
Mejoría de reticulocitos en 1 semana aproximadamente

Desaparición de neutrófilos polisegmentados a las 2 semanas
Aumento de hemoglobina empieza alrededor de 1 semana y normaliza a las 3 semanas aproximadamente
Mejoría de la pancitopenia a las 2 a 4 semanas
Desaparición de síntomas neurológicos entre los 3 a 12 meses
Es un tipo de síndrome de insuficiencia de la médula ósea secundario de las células madre dañadas o defectuosas. Sus rasgos característicos son la pancitopenia, reticulocitos disminuidos, hipocelularidad de la médula ósea y disminución de las células hematopoyéticas.
La anemia aplásica puede ser debido a causas adquiridas o hereditarias:
Adquirida (80-85% de los casos)
– Idiopática (70% de los casos adquiridos)
– Secundaria (10-15% de los casos adquiridos)
– Dependiente de la dosis/previsible
– Fármacos citotóxicos
– Benceno
Cerca del 90% de los casos de anemia aplásica secundaria se producen por reacciones idiosincrásicas
– Radiación
– Idiosincrásica
– Fármacos: compuestos de oro, penicilimina, cloranfenicol, sulfonamidas, carbamazepina, hidantínas, fenacemida, dotlepina, fenotiazina, clorpropamida, tolbutamida, carbutamida, AAS, diclofenaco, ibuprofeno, indometacina, naproxeno, piroxicam, cloroquina, quinacrina, metimazol, metiltiouracilo, metazolamida, mesalazina, acetazolamida, zidovudina (ESSALUD 2016)
– Sustancias químicas: insecticidas, aceites de corte o lubricantes. – Virus
– VEB
Virus de la hepatitis (no A, no B, no C, no G)
– VIH –
Parvovirus B19
– Otras causas
HPN
– Enfermedades autoinmunitarias
Embarazo
Hereditarias (15-20% de los casos)
– Anemia de Fanconi
Disqueratosis congénita
– Síndrome de Shwachman-Diamond
De ahora en adelante nos centraremos en la anemia aplásica adquirida.
La lesión primaria en la anemia aplásica adquirida es la deficiencia cuantitativa y cualitativa de las células madre hematopoyéticas; esto puede deberse a: Daño directo a las células madre Daño inmunitario a las células madre Otros mecanismos desconocidos
Por la insuficiente labor de la médula ósea, los pacientes presentarán elevación de EPO, trombopoyetina, G-CSF y GM-CSF. A pesar de los valores elevados de los factores de crecimiento mencionados, no corregirá la producción de médula ósea, por lo que el paciente cursará con pancitopenia y las consecuencias de este.
Pancitopenia con visceromegalia y/o adenopatías debes pensar en leucemia aguda, pero pancitopenia sin visceromegalia ni adenopatías debes sospechar en anemia aplásica .

Exámenes
Clínica
La clínica del paciente con anemia aplásica adquirida es secundaria a la disminución de las células sanguíneas (pancitopenia):
Síntomas típicos de anemia de aparición insidiosa (palidez, cansancio, debilidad) debido a la disminución de hemoglobina. Petequias, equimosis, epistaxis, gingivorragia, menorragias, hemorragias retinianas, sangrado digestivo e incluso hemorragia intracraneana, todo esto secundario a la plaquetopenia Infecciones bacterianas o micóticas secundario a la leucopenia con neutropenia.
Hemograma con pancitopenia, al inicio puede estar disminuido una o dos líneas celulares
Hemoglobina disminuida generalmente menor de 10 g/dl
VCM aumentado o normal
Reticulocitos disminuidos
Hierro sérico y TIBC estarán incrementados, por la falta de uso de hierro para la eritropoyesis
AMO: “aspiración seca”, también pueden decir hipoplasia medular y aumento de adipocitos.
Biopsia: “médula en damero”
En la evaluación es importante buscar exposición previa a medicamentos.
normal (imagen superior) y una con aplasia medular con el signo de “médula en damero” (imagen inferior)

AA NO GRAVE AA GRAVE AA MG
Médula ósea Hipocelularidad + >2 de: Celularidad < 25% + >2 de: Ídem
Serie roja
Hb < 10 g/dl + Reticulocitos < 30 mil/mm3
Reticulocitos < 20 mil o < 1% corregido para el hematocrito Ídem
Si se trata de una anemia aplásica adquirida de causa conocida, idealmente debe ser eliminada la causa.
Manejo de las citopenias:
Tratamiento y prevención de infecciones
Transfusiones con plaquetas y glóbulos rojos.
Factores de crecimiento como G-CSF, agonistas TPO, EPO

Ante una anemia aplásica idiopática se puede optar por:
Trasplante de progenitores hematopoyéticos
Terapia inmunosupresora intensiva con terapia triple que incluye: globulina antitimocítica de caballo, ciclosporina y eltrombopag.
Estado clínico Capaz de tolerar el HCT
Busqueda de un donante de HCT
El término hemolisis se refiere al aumento de la destrucción de los eritrocitos que acorta su vida útil. Esto da como resultado la reducción de la oxigenación de los tejidos y el aumento de la producción de EPO por el riñón. Frente a esto la médula normal suele responder mediante la aceleración de la producción de eritrocitos, lo que conduce a una reticulocitosis. La anemia hemolítica se produce cuando la velocidad de destrucción supera el aumento de la velocidad de producción de eritrocitos.
Las anemias pueden clasificarse de la siguiente manera:
Aguda versus crónica
Hereditaria versus adquirida
Intrínseca (problemas del propio hematíe) versus extrínseca (por causas externas al hematíe)
Intravascular (fragmentación) versus extravascular (mediada por macrófagos)
Autoinmunes versus no autoinmunes




Causas no inmunes
Hereditario
Deficiencias de enzimas (Ej., Deficiencia de G6PD, piruvato quinasa, glucosa-fosfato isomerasa, 5´nucleotidasa)
Hemoglobinopatías (Ej., Anemia de células falciformes, talasemias, hemoglobinas inestables)
El Síndrome de Evans es la combinación de anemia hemolítica y plaquetopenia.
(ESSALUD 2012)
Defectos de la membrana (Ej., Esferocitosis hereditaria, eliptocitosis hereditaria, estomatocistosis hereditaria)
Adquirido
Enfermedad del hígado
Hiperesplenismo
Infecciones
Agentes oxidantes

Toxinas
Infusión de solución hipotónica
Anemia hemolítica microangiopática (Ej, PTT, SHU, estenosis aórtica, fuga d válvula protésica)
Causas inmunes
Anemia hemolítica autoinmune caliente
Hemolisis inmunitaria inducida por fármacos
Reacciones de trasfusión (Ej, incompatibilidad ABO, alonticuerpos)
Hemoglobinuria paroxística por frio
Hemoglobinuria paroxística nocturna
Enfermedad por crioaglutininas
Infusión IV de Ig o inmunoglobulina anti-RhD
Las anemias hemolíticas hacen cálculos pigmentarios negros.
Clínica
La clínica de las anemias hemolíticas es cursar con la triada clásica :
Anemia
Ictericia
Esplenomegalia (en hemolisis extravascular crónica)
Exámenes
Durante el estudio de la sospecha de una anemia hemolítica podemos encontrar los siguientes resultados de exámenes (ESSALUD 2023):
Anemia
Reticulocitos aumentados
Lámina periférica con esquistocitos en hemolisis intravascular
Haptoglobina disminuida (más disminuida en hemolisis intravascular)
En crisis hemolíticas el VCM es normal.
LDH elevado
Bilirrubinas elevadas a predominio indirecto
Transaminasas elevadas
Reacción leucemoide (Post crisis hemolítica)
Prueba de Coombs positiva en anemias hemolíticas de causa inmune
- En AMO se observa hiperplasia eritroide. (ESSALUD 2007)
Defectos intrínsecos de los glóbulos rojos
Hemoglobinopatías (Ej, Anemia de células falciformes, talasemia)
Defectos de la membrana (Ej, Esferocitosis hereditaria, talasemias)
Defectos de enzimas (Ej, G3PD, deficiencias de piruvato quinasa)
Procesos hemolíticos extrínsecos
Anemia hemolítica autoinmune
Caliente-reactivo
– Enfermedad por crioglobulina
– Hemoglobinuria paroxística por frio
Hiperesplenismo
Enfermedad sistémica
– Infección
– Enfermedad del hígado
– Enfermedad renal
Drogas y toxinas

Microangiopatías
– Síndrome urémico hemolítico (SHU)
Purpura trombocitopenica trombótica (congénita o adquirida)
– Coagulación intravascular diseminada (CID)
Daño mecánico (Ej, Válvulas cardiacas artificiales, fenómenos de Kasabach-Merrit
Enfermedad de Wilson
Mecanismo combinado (intrínseco y extrínseco)
Hemoglobinuria paroxística nocturna (HPN)
Es el tipo más frecuente de anemia hemolítica congénita.
También denominado enfermedad de Minokowski-Chauffard. Es un tipo de anemia hemolítica hereditaria, intrínseca (intracorpuscular), por un problema a nivel de la membrana (membranopatía congénita) debido a la falta de proteínas.
Es debido a mutaciones en genes de proteínas que sirven para la unión entre la membrana y el citoesqueleto. Dichas mutaciones son de herencia autosómica, siendo un 75% de los casos dominante y 25% no dominante.
Proteína deficiente
Alfa-espectrina
Es el tipo más frecuente de anemia hemolítica congénita.
Beta-espectrina
Banda 3
Proteína asociada con Rh
Anquirina
Proteína 4.2
Gen mutado
SPTA1
SPTB
SLC4A1
RHAG
ANK1
EPB42
Tabla 11. Principales proteínas deficientes y sus genes mutados
El defecto en la o las proteínas alteran las interacciones verticales de la membrana entre las proteínas transmembrana y el citoesqueleto subyacente, conllevando a una perdida de secciones de la membrana y/o citoplasma generando también disminución de la relación superficie a volumen; todo eso convierte al eritrocito en forma esférica. De esa manera al pasar por las sinusoides esplénicas pierden más membrana y quedan atrapados y son eliminados con rapidez por los macrófagos de la pulpa roja esplénica (hemolisis extravascular).
También, la membrana de los eritrocitos tiene permeabilidad anormal a los cationes, sobre todo al sodio y potasio; esto conlleva a un aumento del sodio intracelular y disminución del potasio intracelular.
Deficiencia de espectrina anquirina o proteína 4.2
pH bajo Alto contacto con los macrófagos Liberación de microvesículas
Eritrostasis Baja concentración de glucosa
Alta concentración de oxidantes
Hemolisis
Bicapa lipídica
Espectrina
Ankirina Banda 3
Reducción de la relación superficie-volumen
Reduce la deformabilidad de las células
Liberación de microvesículas
Atrapamiento esplénico
Condiciones esplénicas
Más allá de la membrana
Curva de fragilidad osmótica
Deficiencia de Banda-3
La triada clásica de hemolisis es:
1. Anemia
2. Ictericia
3. Esplenomegalia

Clínica

Cursa con la triada clásica. La esplenomegalia está presente en la mitad de los niños y del 75 a 95% de los niños mayores y adultos. Los síntomas pueden aparecer primero en la infancia, la niñez o la edad adulta, o incluso edad avanzada.
Hemoglobina disminuida
Reticulocitos elevados
Lámina periférica con esferocitos (característica distintiva, pero no solo es de esferocitosis hereditaria)
VCM normal o aumentado
CHCM aumentado
RDW aumentado
Test de fragilidad osmótica: el hematíe es más frágil a pocas concentraciones de sodio en la cual el hematíe normal no se lisa.
Prueba de autohemolisis: al incubar la sangre el hematíe sufre más fácilmente lisis (10 a 50%, pero lo normal es menos del 5%)
AMO: con hiperplasia eritroide
Marcadores de hemolisis extravascular
Grado Porcentaje de afectados Hemoglobina Reticulocitos
Tabla 12. Grados de esferocitosis hereditaria
Crisis hemolíticas aplásicas, están asociadas a infecciones virales (por ejemplo, Parvovirus B19)
Deficiencia de vitamina B9 que conlleva a una crisis megaloblástica
Colelitiasis debido a la hemolisis crónica.
Ulceraciones y dermatitis crónica de las piernas son poco frecuentes.

La esplenectomía es el tratamiento curativo de la esferocitosis hereditaria, pero curativo de la hemolisis. Si el paciente no mejora después de la esplenectomía, debes sospechar en un bazo accesorio.
Las formas leves no requieren tratamiento. En casos moderado a graves, la esplenectomía previene la hemolisis significativa desde el punto de vista clínico. Al realizar esplenectomía predispone a un alto riesgo de infecciones por las bacterias capsuladas, por ese motivo se sugiere realizarla después de los 5 o 6 años, además de recibir vacunas contra neumococo, meningococo y H. influenzae, así como profilaxis antibiótica.
Luego de la esplenectomía sigue habiendo esferocitos, pero también empiezan aparecer cuerpo de Howell-Jolly, Dianocitos y cuerpos de Pappenheimer debido a la ausencia del bazo.
En casos graves de esferocitosis hereditaria requieren transfusiones periódicas.
La deficiencia de G6PD brinda protección contra el paludismo.
Es una enfermedad hemolítica debido a una deficiencia de la enzima glucosa-6-fosfato deshidrogenasa, por lo tanto, una alteración de la vía de la pentosa fosfato. Es una de tipo congénita e intrínseca. Es la enzimopatía más frecuente a nivel mundial. Suele ser más frecuente en áreas endémicas de paludismo.
La deficiencia de la enzima se debe a un trastorno recesivo ligado al X, ya que el gen G6PD se encuentra en el cromosoma X. Hay más de 140 mutaciones conocidas del gen G6PD y casi todos son mutaciones de un solo aminoácido.
La G6PD se encarga de mantener al hierro de la hemoglobina en estado reducido y fisiológicamente activo (ferroso) para el transporte de oxígeno y proteger a la hemoglobina del daño oxidativo. Esto lo hace ya que genera NADPH mientras oxida la glucosa-6-fosfato, luego en NADPH restaura al glutatión reducido a partir de un glutatión oxidado. El glutatión reducido reduce peróxido de hidrógeno y radicales de oxígeno para mantener el hierro de la hemoglobina en estado reducido (ferroso) y protegerlo de la desnaturalización oxidativa.
Oxidante
Durante la exposición a oxidantes, los eritrocitos más viejos (que tienen menor G6PD, en comparación con los reticulocitos) son hemolisados de manera preferencial.
Glutatión peroxidasa
Glutatión reducido (GSH)
Glutatión oxidado (GSSG)
NADP
Glutatión - 6 - fosfato
NADPH
6 - fosfogluconato
Glutatión - 6 - fosfato deshidrogenasa
Al haber deficiencia de la enzima G6PD no podrá realizar sus eventos fisiológicos, por lo tanto, la hemoglobina es oxidada a metahemoglobina y después a cuerpos de Heinz (precipitados intracelulares de hemoglobina desnaturalizada que se adhiere a la membrana interna del eritrocito). Se genera un daño de la membrana y perdida de la deformabilidad, lo que lleva a una eliminación con rapidez de la circulación mediante hemolisis intravascular y extravascular.

La mayoría no presenta síntomas en toda su vida y sus eritrocitos solo tienen una vida levemente más corta. Sin embargo, algunos si lo hacen como tres síndromes clínicos:
Anemia hemolítica aguda: debido a un estrés oxidativo por: ciertos fármacos, infecciones o consumo de habas. Estos cuadros agudos suelen presentarse con predominio de hemolisis intravascular. Ictericia neonatal: suele aparecer 2 a 3 días después del nacimiento.
Anemia hemolítica no esferocítica crónica: un pequeño porcentaje de pacientes tiene esta manifestación, cursando con hiperbilirrubinemia crónica. Esta forma crónica es por hemolisis extravascular. En estos pacientes también puede tener episodios agudos frente a condiciones de estrés.
Fármacos
– Dapsona
Azul de metileno
– Nitrofurantoína
Fenazopiridina
– Primaquina – Rasburicasa
– Azul de toluidina
Tabla 13. Fármacos asociados a hemólisis en pacientes con deficiencia de G6PD
Hemoglobina disminuida normocítica normocrómica durante la crisis hemolítica aguda
Reticulocitos elevados
Lámina periférica: hematíes con cuerpos de Heinz Marcadores de hemolisis intravascular durante las crisis. Ensayo cuantitativo de la actividad enzimática de G6PD en los eritrocitos
Primero evitar desencadenantes como fármacos, infecciones, consumo de habas (fabismo). Debido a que la mayoría de los pacientes cursa asintomático, el manejo es expectante; incluso la mayoría de los episodios de crisis hemolíticas se resuelven sin tratamiento, pero podrías llegar a requerir transfusión sanguínea. Aquí no es útil la esplenectomía.
Es una enfermedad hemolítica debido a una deficiencia de la enzima piruvato kinasa, por lo tanto, una alteración de la vía de Embden Meyerhoff. Es una de tipo congénita e intrínseca. Es la segunda enzimopatía más frecuente a nivel mundial.
La deficiencia de esta enzima se debe a una mutación en su gen. Tiene herencia autosómica recesiva. Se han encontrado más de 150 mutaciones.
Normalmente esta enzima se encuentra dentro de la vía de Embden Meyerhoff catalizando la conversión de fosfoenolpiruvato para formar ATP. No se conoce bien los mecanismos exactos que determinan la hemolisis y la disminución de la vida de los eritrocitos. Se sabe que la consecuencia es que disminuya la producción de ATP y aumente el 2,3-difosfoglicerato, este último desvía la curva de disociación de la hemoglobina con el oxígeno hacia la derecha y por consiguiente una disminución de la afinidad por el oxígeno.
La enzima piruvato cinasa cataliza la reacción siguiente:
1. ADP + ácido fosfoenolpirúvico → ATP + acido pirúvico Piruvato cinasa
El ácido pirúvico formado participa luego en la reacción siguiente:
2. Ácido pirúvico + NADH(alta fluorescencia) → Ácido láctico + NAD (sin fluorescencia)
Láctica deshidrogenasa
Su clínica es variada, desde una hemolisis muy agresiva hasta un proceso hemolítico crónico totalmente compensado. La mayoría de los pacientes tienen manifestaciones de hemolisis crónica con anemia, ictericia, esplenomegalia y aumento de la incidencia de cálculos biliares. También puede haber deficiencia de folato (debido a la eritropoyesis acelerada), aplasia medular secundaria a Parvovirus B19 y úlceras cutáneas.
Hemoglobina disminuida
Reticulocitos elevados
Lámina periférica con anisocitosis, poiquilocitosis, policromasia y un número variable de Equinocitos.
Marcadores de hemolisis crónica extravascular
Ensayo cuantitativo de la actividad enzimática de piruvato kinasa en los eritrocitos
No tiene tratamiento específico. Se maneja con transfusiones de eritrocitos de manera periódica según necesidad, y por eso se sugiere utilizar quelantes de hierro. La esplenectomía es beneficiosa en los casos graves, después de esto la hemoglobina sube tanto que reduce o elimina la necesidad de transfusiones.
Es una enfermedad hemolítica del grupo de las hemoglobinopatías de tipo cualitativo (ESSALUD 2018). Es la hemoglobinopatía más frecuente. Esta es una anemia hemolítica congénita e intrínseca. Es más frecuente en la raza afroamericana.

Mutación del gen de la beta globina. Tiene herencia autosómica recesiva.
En la sexta posición de la globina beta el ácido glutámico es sustituido por valina, luego dos globinas beta “erróneas” se unen a dos globinas alfa normales para formar una hemoglobina A “errónea” llamada hemoglobina S (HbS). Cuando la HbS está totalmente oxigenada permanece soluble en el citoplasma del eritrocito, pero al desoxigenarse conlleva a que estas HbS hagan un “apareamiento” entre ellas dentro del eritrocito, volviéndose menos soluble y formando cristales líquidos de polímeros de Hb S que crecen en longitud más allá del diámetro del eritrocito, y esto determina la forma de drepanocitos o células falciformes. Con forme se van formando los eritrocitos falciformes, la sangre se vuelve más viscosa y lenta, para que al final genere la oclusión de las arteriolas y capilares por los drepanocitos y la presencia de infarto de los tejidos circundantes.
Clínica
No presentan síntomas hasta la segunda mitad del primer año de vida debido al efecto protector de la hemoglobina fetal (HbF), ya al final de los primeros 6 meses de vida se empieza a producir cadenas beta mutadas y por ende la formación de HbS, los eritrocitos ahora son susceptibles a la hemolisis y puede manifestarse anemia hemolítica progresiva y esplenomegalia. La característica distintiva de la drepanocitosis es la oclusión vascular.
1. Oclusión vascular
A. Causas
Acidosis, hipoxemia, deshidratación, infección, fiebre, frio extremo
B. Manifestaciones clínicas

La anemia drepanocítica ejerce un efecto protector para malaria.
El paciente con drepanocitosis es susceptible a la infección por Salmonella.
(ESSALUD 2008)
– Huesos: dolor, dactilitis de manos y pies, infección (osteomielitis)
Pulmones: neumonía, síndrome torácico agudo
– Hígado: hepatomegalia, ictericia
Bazo: secuestro esplénico y esplenomegalia, autoesplenectomia (ESSALUD 2002)
– Pene: priapismo
Ojos: hemorragia retiniana
– Sistema nervioso central
Aparato urinario: necrosis papilar renal
– Úlceras de las piernas
2. Infecciones bacterianas
A. Sepsis
B. Neumonía
C. Osteomielitis
3. Defectos hematológicos
A. Anemia hemolítica crónica
B. Crisis megaloblástica
C. Crisis aplásicas
4. Defectos cardiacos
A. Cardiomegalia
B. Soplos cardiacos
5. Otras características clínicas
A. Detención del crecimiento
B. Embarazo de alto riesgo
Hemoglobina disminuida
VCM normal
HCM normal
Reticulocitos elevados
DRW aumentado
Lámina periférica se verá poiquilocitosis y anisocitosis, con eritrocitos en forma semilunar o falciforme, eritrocitos normales, dianocitos, punteado basófilo, cuerpos de Pappenheimer y cuerpos de Howell-Jolly.
Trombocitosis suele estar presente
Médula ósea con hiperplasia eritroide

Inmunoglobulina A elevada
Marcadores de hemolisis crónica extravascular
Para niños y adultos, la combinación de HPLC (cromatografía líquida de alta resolución) e IEF (enforque isoeléctrico de capa fina) permite un diagnóstico definitivo.
La presencia de drepanocitos y dianocitos es la característica distintiva de la drepanocitosis.
El manejo de sostén es crucial e incluye: hidratación adecuada, vitaminoterapia profiláctica, evitar ambientes con poco oxígeno (evitar ejercicio vigoroso, ir a grandes alturas y los viajes con aire no presurizado), uso de analgésicos para el dolor y antibióticos ante los primeros signos de infección.
La exanguinotransfusión es una opción en algunos casos.
Debido al riesgo de infección por bacterias capsuladas, la vacunación contra estas es crucial en los primeros años de vida.
Uso de transfusiones periódicas con uso de quelantes de hierro.
Hidroxiurea se usaría para aumentar la proporción de HbF
Trasplante de médula ósea resulta exitoso en algunas personas.

Las talasemias son un grupo diverso de trastornos hereditarios. Es considerada un tipo de hemoglobinopatía cuantitativa. Es una hemolisis congénita e intrínseca.

Se debe a una alteración genética que reduce o impide la síntesis de una o más de las cadenas de globina del tetrámero de la hemoglobina. Es de herencia autosómica recesiva.
Clasificación
Se dividen en betatalasemias y alfa-talasemias. Aquí revisaremos las beta-talasemias y dentro de ellas principalmente la beta-talasemia mayor.
La beta-talasemia se puede dividir en cuatro síndromes clínicos:
Beta-talasemia mayor
Beta-talasemia intermedia
Beta-talasemia mayor
Beta-talasemia menor
Portador asintomático de beta-talasemia
Se caracteriza por una anemia grave detectada por primera vez en la infancia cuando ocurre en cambio de gamma globina por beta globina, ósea entre los 4 a 6 meses de vida. Generalmente se les diagnóstica entre los 6 meses y 2 años de vida.
Tanto la drepanocitosis y la beta-talasemia suelen empezar entre los 4 a 6 meses de vida, cuando se requiere beta-globina para la formación de hemoglobinas normales.
Clínica

Hepatoesplenomegalia marcada
Ictericia
Cambios óseos marcados
Facies típica de “cara de ardilla” por prominencia de la frente, pómulos y maxilar superior.
Crecimiento físico y desarrollo alterados
Exámenes
Anemia muy severa
VCM muy bajo
HCM muy bajo
Reticulocitos elevados, aunque no tanto a lo esperado.
Lámina periférica con anisocitosis y poiquilocitosis, con dianocitos, formas de lágrimas y eliptocitos.

Radiografía de cráneo con aspecto típico de “cráneo en cepillo”

Los estudios de electroforesis o HPLC muestran que la mayor parte de hemoglobina es HbF, con un aumento leve de la concentración de HbA2
Médula ósea muestra marcada hiperplasia eritroide
Marcadores de hemolisis extravascular
Transfusiones sanguíneas, se suelen iniciar en el primer año de vida. Es la principal opción terapéutica en estos pacientes.
Debido a la hipertransfusión es necesario agregar quelantes de hierro. Esplenectomía es una opción
El trasplante de médula ósea es el tratamiento curativo de la beta-talasemia mayor. Hidroxiurea podría ser una opción, aunque no todos los pacientes parecen responder.
Es un tipo de anemia hemolítica intravascular y crónica rara. Es de condición intrínseca pero adquirida. El inicio del HPN se presenta con mayor frecuencia en la edad adulta, pero también podría ser en niños y ancianos.
Muchos pacientes con HPN tienen antecedente de anemia aplásica adquirida y síndrome mielodisplásico que precede o coincide con la HPN.
Se debe a una mutación clonal adquirida de la célula madre que produce células sanguíneas circulantes que carecen de proteínas de anclaje glucosilfosfatidilinositol. La mutación adquirida ocurre en el gen PIG-A ubicado en el cromosoma X.
El gen PIG-A se traduce en una glucosiltransferasa que se encarga llevar una N-acetilglucosamina al PI (fosfatidilinositol) que se encuentra en la cara interna de la membrana citoplasmática de los eritrocitos, luego este GPI que se acaba de formar pasa a la cara externa de la membrana del eritrocito para convertirse en un anclaje para el CD55 y el CD59. Este C55 y CD59 expresados en la membrana sirven para que el sistema de complemente no reconozca como extraño al eritrocito. En la HPN, por la mutación del gen PIG-A no podrá realizarse estos pasos, por lo tanto, no habrá CD55 ni CD59 en la membrana y el sistema de complemente lo reconocerá como extra activándose una cascada de evento que incluyen hemolisis intravascular crónica, activación de plaquetas, activación de neutrófilos y monocitos, formación de trombos. Además, los pacientes pueden tener disfunción de la médula ósea que contribuye a la gravedad de la anemia.


El paciente cursará con clínica de anemia hemolítica, de trombofilia y de insuficiencia de médula ósea.
Relaciones con la hemolisis intravascular
– Anemia
– Hemoglobinuria
– Cansancio
La trombosis de la vena hepática (síndrome de Budd-Chiari) es la manifestación más frecuente de trombofilia y es una complicación grave, a menudo mortal.
La HPN también cursa con policromatofilia
– Insuficiencia renal crónica
– Colelitiasis
Relaciones con la trombofilia
Trombosis venosa
– Trombosis venosa abdominal: vena hepática (síndrome de BuddChiari), vena esplénica, vena renal
hipertensión portal
– Trombosis venosa cerebral
Trombosis de la vena retiniana y perdida de la visión
– Trombosis de las venas profundas, embolia pulmonar
Trombosis arterial (menos frecuente)
– Accidente cerebrovascular
Infarto de miocardio
Relaciones con la insuficiencia de médula ósea
Pancitopenia: cansancio, infecciones, hemorragia
– Síndrome mielodisplásico
Leucemia mieloide aguda (rara)
Tabla 14.
Exámenes
Hemoglobina disminuida
VCM puede estar ligeramente elevado Reticulocitos elevado leve a moderada Pancitopenia si hay insuficiencia de médula ósea
Marcadores de hemolisis intravascular Médula ósea puede ser normocelular o hiperceular, con hiperplasia eritroide en respuesta a la hemolisis, o puede ser
Eculizumab
Es un anticuerpo monoclonal humanizado dirigido contra la fracción C5 del complemento.
Es el tratamiento de elección, pero no es curativo y no está dirigido a la trombofilia y las complicaciones por la insuficiencia de médula ósea de la HPN.
Requiere vacunación contra meningococo antes de ser usado.
clínicas y complicaciones de la HPN
hipocelular cuando existe insuficiencia de la médula ósea
Para confirmar la HPN se solicita citometría de flujo
Prueba de agua azucarada (prueba de hemolisis con sacarosa) y prueba de Ham (prueba de lisis en suero acidificado. Estas pruebas han sido reemplazadas por la citometría de flujo.
Otros tratamientos:
- Transfusiones
- Antibióticos
Anticoagulantes
Suplemento de hierro y ácido fólico Trasplante de médula ósea, usado en algunos pacientes y podría ser curativo.
Son trastornos caracterizados por destrucción prematura de los eritrocitos y anemia causada por autoanticuerpos que se unen a la superficie del eritrocito con activación del complemento o sin ella.
Los anticuerpos pueden aparecer como consecuencia de:
La desregulación del sistema inmunitario y perdida de la tolerancia inmunitaria
La exposición a un antígeno similar a un antígeno propio
Una neoplasia de linfocitos B
Otra razón desconocida
Este tipo corresponde aproximadamente al 70% de los casos de anemias hemolíticas autoinmunes. Es más frecuente en mayores de 40 años y menores de 4 años.
Idiopática: causa desconocida
Secundaria: trastornos linfoproliferativos (LLC, linfomas de linfocitos B, macroglobulinemia de Waldenstrom), neoplasias no linfoides (timomas y cánceres de colon, riñón, pulmón y ovario), trastornos autoinmunitarios (artritis reumatoide, esclerodermia, poliarteritis nodosa, síndrome de Sjogren, LES), trastornos por inmunodeficiencia e infecciones virales.
Los autoanticuerpos reaccionan de manera óptima a 37 °C y en su enorme mayoría son IgG. En algunos casos involucra a IgA, también a la IgM. La hemolisis es predominantemente extravascular y los casos de hemolisis intravascular fulminante son raros.
Si la AHA de anticuerpos calientes se acompaña de plaquetopenia por PTI, en conjunto se le denominará Síndrome de Evans.
Suele ser de inicio insidioso con síntomas de anemia, pero algunos casos pueden ser agudos y mortales con fiebre, ictericia, esplenomegalia y hepatomegalia, sobre todo en niños con la forma secundaria a infecciones virales.
Hemoglobina con disminución leve a grave
Frotis de sangre con policromasia y esferocitos
Marcadores de anemia hemolítica extravascular
Prueba de PAD (prueba de antiglobulina directa) positivo en 95% de casos, en los casos negativos sugiere que esta mediado por IgA o IgM.
El rituximab es un anticuerpo monoclonal antiCD20.

Manejo
Si es de tipo secundaria, tratar la causa subyacente con frecuencia controla la hemolisis.
Pacientes sintomáticos que no comprometen la vida: Corticoides, se inicia con ellos como por ejemplo la prednisona. Esplenectomía, opción en casos crónicos que no respondan a corticoide o que lo necesiten a largo plazo y a dosis altas.
Rituximab
Fármacos inmunosupresores como ciclofosfamida o azatioprina.
Para pacientes muy graves o que comprometen la vida: Inmunoglobulina endovenosa
Plasmaféresis
Transfusión de eritrocitos
Este tipo corresponde a casi un 25% de los casos de anemias hemolíticas autoinmunes. Tiene prevalencia ligeramente más alta en mujeres y una edad promedio de diagnóstico entre finales de los 60 y principios de los 70 años.
Clasificación
Idiopática: causa desconocida.
Secundaria: en las formas crónicas suele ser secundario a neoplasias linfoproliretivas (linfomas de linfocitos B, macroglobulinemia de Waldstrom, leucemia linfocítica crónica). En las formas agudas suele ser secundario a infección por Mycoplasma pneumoniae, mononucleosis infecciosa y otras infecciones virales.
Las crioaglutininas son autoanticuerpos de la clase IgM que reaccionan de manera óptima entre 3 a 4 °C. Hay crioaglutininas en personas normales, estas son policlonales y se producen en títulos bajos a 4°Cy no tienen actividad por encima de 30°C; casi todas las que causan enfermedad son monoclonales y aparecen en títulos altos a 4°C y son capaces de reaccionar a temperaturas por encima de 30°C. Ya que estas últimas reaccionan a la temperatura corporal, pueden inducir a la enfermedad por crioaglutininas.
El anticuerpo suele ser IgM monoclonal de cadenas ligeras k en las formas crónicas. Es muy probable que las aglutininas frías asociadas con neoplasias linfoides o enfermedad por crioaglutininas crónica asociada con un trastorno linfoproliferativo en la médula ósea sean monoclonales y no se resuelvan espontáneamente ni respondan a los glucocorticoides o la esplenectomía. Si estos individuos tienen una hemólisis significativa, el tratamiento requerirá una terapia para erradicar el clon de células que producen la aglutinina fría.
En las formas agudas las crioaglutininas son IgM policlonales con una distribución normal de cadelas k y L. Es probable que la mayoría de las aglutininas frías asociadas con infecciones o trastornos autoinmunes sean policlonales y se resuelvan espontáneamente con la resolución de la infección (que puede incluir terapia con antibióticos) o el tratamiento del trastorno autoinmune. Se puede aconsejar a estos pacientes que eviten las temperaturas frías hasta que se recuperen.
Tras la exposición al frío los autoanticuerpos IgM se unen a los eritrocitos, sobre todo en la circulación periférica y los vasos sanguíneos de la piel cuando la temperatura disminuye a 30°C. Aquí los autoanticuerpos IgM activan la vía clásica del complemento. Cuando los eritrocitos retornan a la circulación central los anticuerpos se disocian, pero el componente C3b permanece sobre la célula. La hemolisis es predominantemente extravascular, y lo realizan los macrófagos hepáticos, que tienen receptores para C3b. Sin embargo, también podría existir una hemolisis intravascular.
Clínica

En la presentación crónica: Cursan con clínica de anemia leve, aunque algunos pueden llegar a grado severo. Debilidad, cansancio, disnea, palidez, acrocianosis y fenónemo de Raynaud.
En la presentación aguda: pueden tener hemolisis de leve a grave que aparece de forma brusca de 2 a 3 semanas después de la aparición de una infección y se resuelve de modo espontáneo en días o algunas semanas.
Exámenes
Hemoglobina disminuida leve a grave Reticulocitos elevados
Prueba de antiglobulina directa (PAD) positivo Títulos de crioaglutininas
Marcadores de hemolisis extravascular e intravascular de ser el caso.

Manejo
Evitar la temperatura fría
Rituximab
El tratamiento con corticoide o inmunosupresores no suelen ser eficaces en la mayoría de los pacientes.
Esplenectomía, tampoco suele ser eficaz ya que la hemolisis se da principalmente en el hígado. Para casos graves podría indicarse plasmaféresis, de la misma manera que la transfusión de eritrocitos.
La warfarina se controla con TP/INR (ESSALUD 2019), el INR debe estar entre 2 y 3 (ESSALUD 2016), y el antídoto es vitamina K
Los trastornos de hemostasia lo podemos clasificar en base a la fisiología en:
Trastornos de hemostasia primaria
Trastorno de hemostasia secundaria
También es probable que algunos trastornos tengan implicancias en los dos tipos, como por ejemplo la coagulación intravascular diseminada. La importancia de clasificar a los trastornos de hemostasia de esta manera es para seguir un orden y además porque tienen características que los diferencian, como se ilustra en el siguiente recuadro:
Trastornos de hemostasia primaria
Alteración de los vasos (Angiopatías)
- Alt. De pared vascular
Patogenia
- Alt. Del TC perivascular
- Espontáneo o postraumático
- Inmediatos
Alteración de plaquetas (plaquetopatía)
- Trombopenias
- Trombopatías
Trastornos de hemostasia secundaria
Alteración de factores de coagulación (plasmopatías)
- Déficit hereditario de factores
- Déficit adquirido (Ej, ↓VitK)
- Sustancias anticoagulantes
- Trauma o cirugías
- Retrasada (horas o días)
Clínica
- Superficial
- Petequias y equimosis Medidas locales
- #Plaquetas
- Tiempo de sangría
- Profundas
- Hematomas, hemartrosis
- Terapia sistémica
- Tiempo de coagulación
Alteradas
- Fragilidad capilar (Rumpel Leede)
- T. de retracción del coágulo
- Prueba de ADP
- Prueba de Ristocetina
El factor de coagulación IV es el calcio. La heparina se controla con el TTPa, su antídoto es el sulfato de protamina. (ESSALUD 2012)
- TTPa, TP, TT
- Tiempo de Lisis de coagulación
Anteriormente llamado púrpura trombocitopénica idiopática, ahora se le llama trombocitopenia inmune, pero sigue manteniéndose el acrónimo PTI. Esto debido a que se ha demostrado que tanto el PTI agudo y crónico están mediados por mecanismos autoinmunitarios.
Clasificación
PTI agudo PTI crónico
Es principalmente una enfermedad de la niñez, también puede darse en adultos. Se suele presentar entre los 2 a 5 años. No suele haber preferencia del sexo, pero puede ser ligeramente más frecuente en varón.
Fisiopatología
Con frecuencia aparece 1 a 3 semanas después de una infección. La infección a menudo es de tipo viral inespecífico, del tracto respiratorio superior o del tracto gastrointestinal, también otros como sarampión, rubéola, varicela o después de vacunación con virus vivos. Los niños producen anticuerpos y complejos inmunitarios contra antígenos virales y la destrucción de las plaquetas resulta de la unión de estos anticuerpos o complejos a la superficie de las plaquetas.
Los PTI que cursan con plaquetopenia menor de 10 000 plaquetas/mm3 tienen alto riesgo de hemorragia intracraneal.
No hay análisis específico para el diagnóstico de PTI aguda o crónica.
El PTI agudo suele tener remisión espontánea
(ESSALUD 2014)
Es de presentación brusca, caracterizada por petequias, equimosis y a veces sangrados como epistaxis o gingivorragia, en un niño que de base es sano; incluso en casos graves desarrollan sangrados gastrointestinales, hematuria, hemorragia intracraneana y hemorragia retiniana. Un 10 a 15% de pacientes que fueron catalogado como PTI agudo terminan siendo PTI crónico.

Exámenes
Plaquetopenia, generalmente más baja que una crónica, es decir puede llegar menos de 20 000 plaquetas/mm3
Leucocitos y hematíes normales, excepto que la hemoglobina puede estar un poco baja por los sangrados.
Estudios de TP, TTPa, TT son normales.
La mayoría de los pacientes con PTI aguda se recupera con o sin tratamiento en un tiempo aproximado de 3 semanas, aunque algunos pueden durar algunos meses. Incluso puede haber episodios de recurrencia en algunos niños. La mayoría son cuadros leves que no requieren tratamiento, sin embargo, otros más severos pueden requerir corticoides, inmunoglobulina intravenosa e incluso hasta esplenectomía. Idealmente la transfusión de plaquetas no debería darse a menos que haya riesgo de comprometer la vida.
Este tipo puede encontrarse en pacientes de cualquier edad, aunque la mayoría de los casos corresponde a pacientes entre los 20 a 50 años. Aquí si hay una mayor frecuencia de casos en mujeres en una relación de 2:1 o 3:1 con respecto a los varones.
Fisiopatología
La destrucción de las plaquetas es el resultado de un proceso autoinmunitario. Los anticuerpos atacan a las plaquetas y, como resultado, las plaquetas marcadas con ellos son retiradas de la circulación por las células reticuloendoteliales, principalmente el bazo. En 50 a 60% de los casos se ha encontrado anticuerpos dirigidos contra las glicoproteínas de la superficie plaquetaria. El factor productor de la trombocitopenia en el plasma del paciente con PTI es un anticuerpo de tipo IgG
Clínica

La PTI crónica generalmente empieza de manera insidiosa asociado a plaquetopenia en forma variables y a veces con periodos normales. Los síntomas en la presentación son aquellos de hemorragia mucocutánea con menorragia, epistaxis recurrente y equimosis.
Exámenes
Plaquetopenia, generalmente no tan baja como en el agudo, ósea entre 20 000 y 80 000 plaquetas/mm3, las plaquetas tienen un tamaño aumentado. Leucocitos y hematíes normales, excepto que la hemoglobina puede estar un poco baja por los sangrados.
Estudios de TP, TTPa, TT son normales. Médula ósea, presenta hiperplasia de los megacariocitos.
Manejo
Las armas terapéuticas son similares que en el PTI agudo, es decir, corticoides, inmunglobulina intravenosa, esplenectomía, inmunoglubina Anti-D intravenoso. Diferencias entre PTI agudo y crónico.
Características PTI agudo PTI crónico
Edad de aparición 2 a 5 años 20 a 50 años
Sexo más afectado Ninguno o ligero aumento en mujeres
Mujeres más que varones 2:1 o 3:1
Infección previa Común Rara
Aparición de la hemorragia Repentina Gradual
Recuento de plaquetas <20 000/mm3
Duración 2 a 6 semanas
20 000 – 80 000/mm3
Meses o años
Remisión espontánea 90% de los pacientes Infrecuente
Patrón estacional Mayor incidencia en invierno y primavera Ninguno
Terapia
- Corticoide
- Esplenectomía
Respuesta:
- 70% de respuesta
- Raramente necesario
Respuesta
- 30% de respuesta
- <45 años: 90% de respuesta; >45 años: 40% de respuesta.

Existe dos tipos de PTT: Hereditario, también denominado síndrome de Upshaw-Shulman. Es debido a una mutación del gen del ADAMTS13.
Adquirido, también denominada síndrome de Moschcowitz. Es debido a la producción de anticuerpos contra la enzima ADAMTS13
Aquí revisaremos el tipo adquirido. Es una enfermedad infrecuente pero no rara. Se presenta más frecuentemente en mujeres que en varones, entre las edades de 30 a 40 años. Aproximadamente la mitad de los pacientes que desarrollan PTT tienen antecedentes de enfermedad de tipo viral varios días antes de la aparición de PTT.
Al parecer el PTT se debe a la acumulación de multímeros excepcionalmente grandes del factor de Von Willebrand (FvW) en el plasma del paciente. Normalmente los multímeros grandes del FvW se escinden a multímeros más pequeños por acción de la metaloproteasa llamada ADAMTS13.
En en PTT adquirido hay anticuerpos con la enzima ADAMTS13, eso condiciona a que no pueden escindirse los multímeros de FvW, por lo tanto, se desarrollará trombos hialinos en las arteriolas terminales y capilares. Estos trombos hialinos están formados por plaquetas y factor de Von Willebrand, pero contienen muy poca fibrina o fibrinógeno. A medida que se depositan estos trombos, se desarrolla trombocitopenia por consumo. Guardan una relación, cuantos más trombos se forman hay más trombocitopenia. Luego, los eritrocitos que fluyen por los vasos chocan con estos trombos y terminan fragmentados (hemolisis). Las lesiones trombóticas también dan origen a otras manifestaciones porque se depositan en la vasculatura de todos los órganos. Los trombos ocluyen el flujo de sangre y producen isquemia de los órganos: sistema nervioso, retina, riñón, tracto digestivo.

En la PTT, la anemia hemolítica microangiopática y la plaquetopenia se presentan en el 100% de los casos.
El paciente cursará con clínica de anemia, pero además por las lesiones trombóticas en órganos presentará síntomas neurológicos como cefalea, convulsiones, focalización, parestesias y confusión hasta coma; alteraciones visuales por daño neurológico o por daño de retina; por afectación renal cursará con proteinuria y hematuria, generalmente no llega a daño renal intenso con anuria y uremia fulminante; hemorragias gastrointestinales por plaquetopenia o dolor abdominal por oclusión de la microcirculación mesentérica. Además, otros síntomas en el momento del diagnóstico son diarrea, anorexia, náuseas, debilidad y fatiga.
Lo característico es que curse con una pentada:
1. Anemia hemolítica microangiopática
2. Plaquetopenia por consumo
3. Clínica neurológica
4. Lesión renal
5. Fiebre
En la PTT los resultados de TP, TTPa, TT, fibrinógeno y dímero-D son normales, y eso ayuda a diferenciarlo de la coagulación intravascular diseminada (CID), ya que en esta última están alterados. No se solicita AMO para diagnóstico de Enfermedad de Von Willebrand (ESSALUD 2003)
Hemoglobina disminuida Reticulocitos aumentados Lámina periférica con esquistocitos, también microesferocitos y queratocitos. Plaquetopenia Marcadores de hemolisis intravascular Médula ósea con hiperplasia eritroide y aumento del número de megacariocitos.
TP, TTPa, TT, fibrinógeno y dímero-D son normales Pruebas de actividad de ADAMTS13 disminuida Anticuerpos contra el ADAMTS13 positivos
La púrpura trombocitopénica trombótica (PTT) es una emergencia médica que casi siempre es mortal si no se inicia de inmediato el tratamiento adecuado.
El intercambio de plasma terapéutico es el pilar del tratamiento para todas las personas con un diagnóstico presuntivo de PTT basado en una puntuación PLASMIC en el rango de riesgo intermedio a alto (5 a 7 puntos) y confirmado por un hallazgo de deficiencia severa de ADAMTS13.
Los glucocorticoides de forma rutinaria se usarían para todos los pacientes Rituximab para todos los pacientes con PTT confirmada Caplacizumab para pacientes seleccionados.

El FvW tiene su gen en el cromosoma 12, es una glucoproteína que se sintetiza en el endotelio (almacena en los cuerpos de Weibel-Palade), aunque también en los megacariocitos (almacenado en los gránulos alfa de las plaquetas). Y son liberados por varios estímulos hemostáticos.
La enfermedad Von Willebrand es un problema congénito, es considerado como la diátesis plaquetaria congénita más frecuente y la causa más frecuente de hemorragia hereditaria. Afecta a ambos sexos por igual.
Está causada por cualquiera de varias docenas de mutaciones de la línea germinal que producen anomalías cuantitativas y estructurales (cualitativas) en el FvW. Tiene un patrón de herencia autosómica dominante (en la mayoría de los casos) y recesivo.
Las funciones del FvW son:
- Protege al factor VIII de la proteólisis, prolongando su semivida plasmática
- Adhesión plaquetaria, uniendo colágeno subendotelial con GpIb de las plaquetas
- Agregación plaquetaria, uniendo las plaquetas con GpIIb/IIIa de las plaquetas
El tipo más frecuente es el tipo 1 y el tipo más grave es el tipo 3.
Las anomalías estructurales (cualitativas) o cuantitativas del FvW reducen la adhesión plaquetaria y por ende también la agregación plaquetaria. En casos de deficiencia cuantitativa grave genera una deficiencia adicional del factor VIII.
Tipo 1: es una deficiencia cuantitativa parcial. Representa el 75 % de los casos.
Tipo 2: es una variante cualitativa. Tiene varios subtipos:
♦ Tipo 2-A: es una deficiencia selectiva de multímeros de alto peso molecular, unión reducida a Gp-Ib plaquetaria. Representa el 10 a 20% de los casos.
♦ Tipo 2-B: unión mejorada de multímeros de alto peso molecular a GP-Ib plaquetaria; puede haber una disminución en los multímeros circulantes de alto peso molecular. Representa el 5% de los casos.
♦ Tipo 2-M: unión reducida de FvW a GP-Ib plaquetaria. Es poco común.
♦ Tipo 2-N: unión reducida del FvW al factor VIII. Es poco común.
Tipo 3: deficiencia cuantitativa severa/ausencia del FvW. Es raro.
Los tipos 1 y 2 cursan con sangrados por traumatismos, y el tipo 3 cursa con sangrados espontáneos.
El tipo 2N es conocido como variante Normandía o hemofilia autosómica.
Cursa con hemorragias mucocutáneas de variada gravedad:
Epistaxis
Equimosis
Hemorragias digestivas
Hemorragias quirúrgicas
Si la alteración del FvW es grave genera una deficiencia adicional del factor VIII, por consiguiente, se asociaría sangrados en tejidos blandos.
Antecedentes familiares de sangrados mucocutáneos.
Exámenes
Se debe solicitar las siguientes pruebas:
Hemograma, en busca de plaquetopenia que orientaría al tipo 2-B
Pruebas de hemostasia secundaria como TTPa el cual estaría prolongado en casos graves
Prueba cuantitativa del FvW
Prueba de actividad del FvW
Ensayo de actividad del factor VIII
Prueba de ristocetina (RIPA)
Análisis de multímeros de FvW por electroforesis en gel de poliacrilamida
Tabla 18. Cuadro comparativo de clínica y exámenes de los tipos de enfermedad de Von Willebrand
Las opciones terapéuticas incluyen:

Desmopresina (DDAVP), es eficaz en el tipo 1, en general útil en el tipo 2-A, podría usarse en el tipo 2-M y 2-N, en el tipo 2-B no se debe usar, excepto algunas excepciones, en el tipo 3 no se recomienda.
Concentrado de FvW derivado del plasma (todas las presentaciones incluyen factor VIII), puede ser usado en todos los tipos.
Concentrado de FvW recombinante, se pueden usar con o sin factor VIII. Pueden ser usados en todos los tipos.
Crioprecipitado y plasma fresco congelado son alternativas, aunque menos deseadas.
Las hemofilias son coagulopatías congénitas debido a la deficiencia de un factor de coagulación de la hemostasia secundaria.
Hemofilia A
Hemofilia B
Hemofilia C
Hemofilia A
Se presenta por la deficiencia del factor VIII, representa el 85% de los casos de hemofilias. Es también conocida como “hemofilia clásica”.
El gen del factor VIII se ubica en el cromosoma X, el problema es que ocurre delecciones, mutaciones de terminación, de pérdida de sentido y de cambio de sentido. Como el gen se encuentra en el cromosoma X, se trata de una enfermedad ligada al sexo y recesiva.
Clínica
Por ser un trastorno de hemostasia secundario cursa con sangrados profundos como: Hemartrosis (la más frecuente), van con dolor intenso y limitación funcional. Además, cuando son recurrentes producirá una artropatía crónica.
Hematoma de músculos
Hematoma de órganos como riñón, hígado, tracto digestivo. Sangrados en el sistema nervioso central Los sangrados suelen manifestarse con una demora de varias horas, pero pueden ser también inmediatos al suceso desencadenante. Algunas hemorragias pueden incluso ser espontáneas.
Los pacientes sintomáticos son varones cuyo único cromosoma X tiene el gen del factor VIII mutado. Las mujeres suelen ser portadoras sin síntomas, pero hay casos en que la mujer puede ser sintomática.
Los pacientes pueden ser clasificados según la gravedad, en base a la actividad del factor VIII:
Severo: <1% de actividad del factor VIII
Moderado: 1 a <5% de actividad del factor VIII
Leve: >5 a 40% de actividad del factor VIII


La complicación más frecuente de la hemofilia es la artropatía crónica.
Se solicitará pruebas en hijo de madre con antecedentes familiares de hemofilia. Si no hay antecedentes familiares se sospechara si hay signos de sangrado en etapa neonatal. En casos graves el diagnóstico se suele hacer en el primer año de vida, en casos leves se retrasan hasta la niñez, adolescencia o adultez y después de un evento desencadenante.


Las pruebas de laboratorio serían:
Actividad del factor VIII
Se debe solicitar TP, TTPa y TT, de ellos solo el TTPa estará prolongado.
El objetivo del tratamiento es elevar la actividad del factor VIII del paciente hasta un nivel hemostático dependiendo de la demanda, es decir, cada vez que experimente o sospeche un episodio de hemorragia o anticipe un desafío para la hemostasia como un procedimiento quirúrgico.
El nivel de actividad deseado depende de la naturaleza de la hemorragia y debe mantenerse hasta que se resuelva la amenaza.
Las opciones terapéuticas son:
Desmopresina (DDAVP), aumentará la actividad del factor VIII
Concentrado de factor VIII recombinante (no contiene FvW)
Concentrado de factor VIII derivado del plasma (contiene FvW)
Plasma fresco congelado
Crioprecipitado
Antifibrinolíticos
El factor VIII tiene una semivida de 8 a 12 horas, por tal motivo debe brindarse 2 veces al día.
Fisiología: el factor IX es una serinproteasa dependiente de vitamina K. El factor IX es activado por el factor VII activado y el factor XI activado. Luego, factor IX activado se encarga de la activación del factor X.
Es también conocida como “enfermedad de Christmas”. Representa aproximadamente el 14% de los casos de hemofilia. Esta enfermedad se debe a deficiencia del factor IX.
Debido a la deficiencia del factor IX se reduce la formación de trombina, su gen se encuentra en el cromosoma X, por lo tanto, se trata de una enfermedad ligada al sexo y de herencia recesiva. Involucra a más de 220 mutaciones.
La presentación clínica es indistinguible de la hemofilia A. Los pacientes pueden ser clasificados según la gravedad, en base a la actividad del factor IX:
Severo: <1% de actividad del factor IX
Moderado: 1 a <5% de actividad del factor IX
Leve: >5 a 40% de actividad del factor IX

Se solicitará pruebas en hijo de madre con antecedentes familiares de hemofilia. Si no hay antecedentes familiares se sospechara si han signos de sangrado en etapa neonatal. Las pruebas de laboratorio serían:
Actividad del factor IX
Se debe solicitar TP, TTPa y TT, de ellos solo el TTPa estará prolongado.
Las opciones terapéuticas son:
Concentrado de factor IX recombinante

Concentrado de factor IX derivado del plasma
Plasma fresco congelado
Antifibrinolíticos
El factor IX administrado tiene una semivida de 24 horas, por tal motivo debe brindarse 1 vez al día.
El factor IX y el factor XI no se encuentran en el crioprecipitado, por lo que no son útiles en el manejo de hemofilia B y C.
Este tipo de hemofilia se debe a la deficiencia del factor XI. Es también llamada síndrome de Rosenthal. Representa menos del 1% de casos de hemofilia. El gen del facto XI se encuentra en el cromosoma 4. Su herencia es autosómica dominante o recesiva. Sus síntomas de sangrado suelen ser leves a moderados. La gravedad se clasifica en parcial (entre el 20 a 60% de funcional del factor XI) o grave (menos del 20% de funcionalidad del factor XI). Aquí también solo el TTPa se encuentra prolongado. Las opciones terapéuticas incluyen plasma fresco congelado, concentrado de factor XI derivado del plasma, antifibrinolíticos.
La CID aguda suele ser mortal y requiere intervención médica inmediata.
La sepsis es la causa más frecuente de CID.
Es una activación generalizada de la hemostasia secundaria a una enfermedad sistémica, y a menudo es mortal. Implica el consumo aumentado de todos los factores de coagulación incluyendo a las plaquetas, así como, el aumento de los productos de la degradación de fibrina (PDF). Otros nombres usados son: síndrome de desfibrinación o coagulopatía por consumo.
Una manera de clasificar a la CID es en:
Aguda y descompensada: cursa con deficiencia de múltiples componentes de la hemostasia.
Crónica: con componentes de la hemostasia normales o incluso elevados, lo que ocurre es que el hígado con más producción de factores y la médula ósea con más producción de plaquetas, compensan el mayor consumo.
Causas agudas:
Septicemia
Emergencias obstétricas (aborto frustro, abruptio placentae)
Hemolisis intravascular
Viremia
Quemaduras
Inflamaciones agudas
Lesiones por compresión
Aneurisma disecante de la aorta
Trastornos cardiacos
Causas crónicas:
Neoplasias malignas: cáncer de páncreas, próstata, ovario y pulmón, mieloma múltiple y enfermedades mieloproliferativas.
Tumores vasculares
Necrosis de los tejidos
Enfermedad hepática
Enfermedad renal
Inflamación crónica
Uso de dispositivos protésicos
Los factores desencadenantes pueden activar la coagulación en cualquier punto de la vía. El siguiente esquema explica los eventos que se presentan:
Consumo de plaquetas
↓Plaquetas
Activación de la coagulación intravascular
Deposito de fibrina
Consumo de factores de coagulación
↑PT ↑aPTT
CONDICIÓN SUBYACENTE
Activación de neutrófilos Activación/ daño endotelial
Fibrinolisis Formación NET
↑Dinero D ↑FDPs
↑ADN complejo histona
↑ADNds Esquistocitos
MAHA
Un resultado normal de dímero-D descarta la CID, así como una trombosis venosa profunda y la embolia pulmonar.
Deterioro de la coagulación SANGRADO
Trombosis microvascular
ISQUEMA DE ÓRGANOS/ FALLO DE ÓRGANOS
Clínica

El tipo agudo se presenta con mayor clínica de sangrado, mientras que el tipo crónico se presenta con signos de isquemia.
Exámenes
Como se observó en el esquema de la fisiopatología, las pruebas alteradas en una CID son:
Plaquetopenia
TP, TTPa, TT prolongados Fibrinógeno disminuido
Dímero-D y los productos de la degradación de fibrina (PDF) elevados Esquistocitos en lámina periférica
Lo fundamental es el manejo de la enfermedad de base. Las opciones terapéuticas incluyen:
Terapia de reemplazo de plaquetas y factores de coagulación, esto incluye transfusión de plaquetas, plasma fresco congelado y crioprecipitado.
Terapia que hacen más lento el proceso de coagulación como por ejemplo la heparina, pero con mucho cuidado porque puede agravar el sangrado en una CID aguda, podría ser más beneficioso su uso en una CID crónica.
Los leucocitos y plaquetas ocupan el 1% del volumen de la sangre.
Según estirpe:
Las leucemias son neoplasias hematológicas que nacen en la médula ósea, se clasifican como agudas debido a la proliferación de células blásticas en médula ósea. Es la neoplasia más frecuente en pediatría (ESSALUD 2004). Su frecuencia en general suele ser mayor en varones.
Leucemia aguda linfoide (LAL)
Leucemia aguda mieloide (LAM)
Si una leucemia aguda se presenta en niños, lo más probable es que sea del tipo linfoide con una mayor frecuencia entre los 2 a 5 años, mientras que en adultos lo más probable es que sea mieloide y preferentemente en mayores de 60 años.
Además, cada una de ellas puede ser clasificada en base a la morfología según la clasificación franco-americana-británica (FAB):
El LAM-M2 es el tipo de LAM más frecuente y el de mejor pronóstico. Mientras que los M4, M5, M6 son de mal pronóstico.
De la misma manera hay marcadores bioquímicos que se usan para orientar la clasificación de LAL y LAM:
Según la etiología: De novo, es decir sin ninguna enfermedad previa que lo predisponga. Secundaria, como su nombre lo dice aparece en el contexto de otros procesos como, por ejemplo, síndrome mielodisplásico, síndromes mieloproliferativos crónicos o hemoglobinuria paroxística nocturna.
LAL LAM
CD: 34
LB: 19, 20
LT: 1,2,35,7
Fosfatasa ácida (+) (LAL-T)
PAS (L1, L2)
CD: 13, 33, 34
Mieloperoxidasa
Sudan negro Esterasa no específica
PAS
TdT 90% (Menos en L3) Bastones de Auer
Debido a una causa desconocida aún, una de las células blásticas en la médula ósea se convierte en una célula neoplásica la cual comienza a proliferar dentro del espacio limitado de la médula ósea, esto conlleva a que desplace a las otras células normales blásticas y células en maduración, haciendo que disminuya su número. Por lo tanto, las células normales saldrán al torrente sanguíneo en menor número con la consiguiente disminución de células en sangre, mientras que las células blásticas neoplásicas abundantes en la médula ósea saldrán también en gran cantidad al torrente sanguíneo. Estos procesos hacen que en la sangre se vea una disminución de las células normales (pancitopenia) y un gran número de células blásticas. Además, estas células neoplásicas pueden infiltrar otros tejidos como hígado, bazo, hueso, mediastino, SNC, testículos, etc.
Los tipos M4 y M5 de las LAM suelen infiltrar piel, encías y SNC.
Los tipos de LAM asociados a CID son el M3 (más frecuente) y el M5 (menos frecuente).

Debido a la pancitopenia y la infiltración de tejido el paciente cursará con:
Anemia: palidez, taquicardia, cansancio.
Plaquetopenia: petequias, equimosis, epistaxis, gingivorragia.
Leucopenia: infecciones importantes.
Debido a la infiltración de tejidos: visceromegalia y adenopatías. Las infiltraciones de hígado, bazo, hueso, mediastino, SNC, testículos son más frecuentes en LAL.
También los pacientes cursan con dolores óseos. Por otro lado, los pacientes pueden cursar con CID siendo más frecuente en las LAM.
Exámenes
Hemograma: pancitopenia (leucopenia, anemia, plaquetopenia), es probable que en un hemograma automatizado arroje leucocitosis, pero esto es porque la maquina reconoce a las células blásticas como leucocitos y lo contabiliza dando una leucocitosis. Además, se encuentra gran número de células blásticas .
Aspirado de médula ósea: hipercelularidad por células blásticas, para hacer el diagnóstico se debe encontrar células blásticas en más del 20% de la celularidad de la médula ósea.
El AMO se suele realizar en esternón, crestas iliacas o platillos tibiales.
Manejo de sostén: se basa en manejar las anemias severas, sangrados e infecciones con transfusiones de paquete globular, transfusión de plaquetas y antibióticos, respectivamente.
Manejo específico: consiste en el manejo de la neoplasia en sí misma.
Inducción a la remisión: se realiza con poliquimioterapia, si se trata de una LAM-M3 se tiene que agregar ácido transretinoico y si es LAL se debe agregar profilaxis del SNC con metrotexate.
Consolidación: se realizará al alcanzar la remisión y se brinda quimioterapia adicional en niños con riesgo elevado y en todos los adultos.
Trasplante de progenitores hematopoyéticos (TPH): Si el paciente presenta una recaída durante el tratamiento o en el primer año postratamiento o si no logra la remisión completa o si es que la logra, pero tiene factores de mal pronóstico.
Criterios de remisión completa
La remisión completa se suele lograr en un 70-90% en LAL y en un 60-80% en LAM.
- Menos de 5% de blastos en médula ósea

- Ausencia de células leucémicas en sangre periférica
- Restauración del número de células en sangre periférica
- Ausencia de hallazgos físicos por afectación extramedular
Buen pronóstico Mal pronóstico
Niños: 1 a 9 años
Edad
Adultos: 15 a 30 años
Niños: <1 año y > 9 años Adultos: > 30 años
Sexo Mujer Varón
Leucocitos < 25 000 >50 000
Subtipo L1 L3>L2>L1
Etiología De novo
Citogenética Hiperploidia (>50 cromosomas)
Secundario
T (9:22)
T (8:14)
T (4:11)
T (1:19)
Infiltración del SNC No Si
Tabla 22. Factores de buen y mal pronóstico en LAL
Buen pronóstico Mal pronóstico Edad < 60 años >60 años
Sexo Mujer Varón
Leucocitos < 100 000 >100 000
Subtipo M1, M2, M3, M4Eo M4, M5, M6
En general las LAL tienen mejor pronóstico que las LAM.
Etiología De novo Secundario
T (9:22)
Delección 5
Citogenética
T (8:21)
T (15:17)
T (16:16)
Delección 7
T (6:9)
Inversión cromosoma 3
Trisomía 13
Infiltración del SNC No Si
Tabla 23. Factores de buen y mal pronóstico en LAM
Las leucemias son neoplasias hematológicas que empiezan en la médula ósea, se les asigna el término crónica debido a que las células que proliferan son “células en maduración”, además el término linfoide es por la estirpe al cual pertenece la célula neoplásica. Las LCL pueden ser derivadas de linfocitos T o B, lo más frecuente es que sea de tipo B. Es el tipo de leucemia más frecuente en adultos.
La etiología es desconocida, pero se asocian a alteraciones cromosómicas como la trisomía 12. También están asociadas a conectivopatías e inmunodeficiencias.
La LCL es el tipo de leucemia más frecuentemente asociada a problemas autoinmunes.
Debido a una etiología que aún no se conoce, una célula linfoide en maduración en la médula ósea empieza a proliferar ocupando el espacio limitado de la médula ósea y desplazando a las otras células normales en maduración, así como las células blásticas normales. De esta manera, cuando salgan las células a la sangre, saldrá una gran cantidad de células linfoides neoplásicas en maduración, pero saldrá una poca cantidad de células normales no linfoides; esto conlleva a una disminución de células sanguíneas normales (disminución de eritrocitos, disminución de plaquetas y disminución de los otros leucocitos). Es importante recordar que, si bien salen gran cantidad de linfocitos neoplásicos, estos no serán funcionales por lo que el paciente estaría comprometido inmunológicamente, es decir en otras palabras serán “linfocitos erróneos”. Además, las células neoplásicas pueden infiltrar otros tejidos como hígado, ganglios, bazo, piel, parótidas.
Por otro lado, la LCL se puede asociar con problemas autoinmunes como anemia hemolítica autoinmune y trombocitopenia inmune secundaria.
La infiltración de glándulas parótidas se le llama síndrome de Mickulicz.
Debido a la disminución de células normales en sangre periférica y a la infiltración de tejidos, el paciente tendrá:
Anemia: palidez, taquicardia, cansancio, fatiga.
Plaquetopenia: petequias, equimosis, epistaxis, gingivorragia.
Leucocitos normales disminuidos: predisposición a infecciones.
Infiltración de tejidos: adenopatías, visceromegalia, infiltrado en piel, este último es típico de la LCL de células T.
Hemograma: se encontrará anemia, plaquetopenia, leucocitosis por gran linfocitosis (recuerda que son linfocitos no funcionales), lo otros leucocitos estarán disminuidos. Los linfocitos suelen ser más de 5000 células/mm3 o más de 75% de los leucocitos.

Aspirado de médula ósea: determina el diagnóstico, se encontrará hipercelularidad linfoide por proliferación de células linfoides neoplásicas en maduración correspondiente a más del 30% de células de la médula ósea.
Lámina periférica: los “linfocitos erróneos” se observarán alterados en su forma dando un aspecto conocido como “sombras de Gumprecht”
Se clasificación según Binet en A, B y C; de la siguiente manera:
Que la saturación es la primera evaluación y es periférica SpO2 o del AGA SaO2 y esta es <90% en la IRA1.
Estadio Características Porcentaje Riesgo/ supervivencia
A Ausencia de anemia y plaquetopenia < 3 áreas ganglionares aumentadas de tamaño 60% Bajo >10 años
B Ausencia de anemia y plaquetopenia >3 áreas ganglionares aumentadas de tamaño 30% Mediano 5 años
C Anemia y/o trombocitopenia Cualquier número de áreas ganglionares aumentadas de tamaño
10% Alto 2.5 años
Binet A: Observación

Binet B y C: quimioterapia con o sin corticoides y/o rituximab
Quimioterapia: en ancianos suele ser monoterapia con clorambucilo, en jóvenes con poliquimioterapia con fludarabina, ciclofosfamina y rituximab.
Corticoides y/o rituximab: se suele asociar en el tratamiento cuando cursan con problemas autoinmunes. Los pacientes suelen fallecer por problemas infecciosos, esto debido al estado de inmunodepresión con el cual cursan.
La leucemia es una neoplasia hematológica que nace en la médula ósea, se clasifica como crónica ya que la célula que prolifera es una célula maligna en maduración y se dirá que es mieloide porque los leucocitos que proliferan son de la estirpe mieloide.
La LCM es considerado como uno de los 4 tipos de síndromes mieloproliferativos crónicos, junto a policitemia vera, mielofibrosis idiopática y trombocitosis esencial.
Cuándo un cromosoma o parte de él se une a otro cromosoma se llama translocación.
Es de causa desconocida, pero se asocia a la translocación adquirida entre el cromosoma 9 y 22, esto formará el cromosoma Filadelfia, el cual está presente en el 95% de pacientes con LCM. El cromosoma Filadaldia brinda un buen pronóstico.
El cromosoma Filadelfia, el cual se adquiere por una translocación entre el cromosoma 9 y 22, formará un oncogen llamado BCR-ABL el cual se traduce en una tirosin kinasa, esta estimula la proliferación celular de manera acelerada y descontrolada en la médula ósea. Las células que proliferan son células de la estirpe mieloide en maduración, esto hace que las demás células normales de la médula ósea sean desplazadas. Las células que salgan a la sangre serán en gran cantidad células mieloides neoplásicas y en poca cantidad las demás células normales (eritrocitos, plaquetas y linfocitos). Las células mieloides neoplásicas suelen ser con mayor frecuencia los neutrófilos, aunque también los basófilos y eosinófilos, e incluso monocitos. Las células neoplásicas también llegan a infiltrar tejidos como bazo, hígado y ganglios.

En la LCL es más frecuente las adenopatías que la visceromegalia, pero en la LCM es más frecuente la visceromegalia que las adenopatías.
Clínica

La presentación del paciente lo podemos dividir en tres fases:
Fase crónica
Fase acelerada
Fase blástica
La fase crónica se caracteriza por signos de anemia (cansancio, fatiga, palidez), plaquetopenia (petequias, equimosis, sangrados), linfopenia y leucocitosis por mielocitos no funcionantes (infecciones), además por la gran proliferación de leucocitos neoplásicos en sangre puede ocasionar signos de leucostasis (alteraciones visuales, cefalea, obnubilación, priapismo). También cursará con síntomas generales y dolores óseos. En la fase acelerada los leucocitos aumentan aún más, tienen menor maduración, anecdóticamente cursa con trombocitosis y liberación de células blásticas y un empeoramiento clínico con fiebre, sudoración y mayor esplenomegalia. La fase blástica es la transformación de la LCM en una LAM (con mayor frecuencia) o también como una LAL.
Exámenes
Hemograma: anemia, plaquetopenia, gran leucocitosis (entre 50 a 250 mil células/mm3) (ESSALUD 2002) con neutrofilia, eosinofilia y basofilia. En la fase acelerada cursará con trombocitosis e incluso células blásticas. En la fase blástica habrá células blásticas.

Aspirado de médula ósea: brinda el diagnóstico y se encontrara una hipercelularidad mieloide.
Figura 37.
Recuerda
La LCM es la leucemia que más leucocitosis genera.
Lámina periférica con gran cantidad de leucocitos en LCM
En la fase crónica el manejo se basa en quimioterapia siendo la de elección el imatinib, pero como tratamiento curativo se tiene al trasplante de progenitores hematopoyéticos (TPH). Para la fase acelerada o blástica no hay manejo efectivo, aunque podría usarse el imatinib o TPH.
Pronóstico
Su pronóstico ha mejorado gracias al imatinib con una supervivencia hasta 90% en 5 años. El 80 a 90% fallecen por cursar con una crisis blástica.
Los síndromes mieloproliferativos crónicos son:
Leucemia crónica mieloide

Policitemia vera
Uno de los manejos de policitemia secundaria a vivir en altura es vivir a nivel del mar.
Mielofibrosis idiopática
Trombocitosis esencial
Es un tipo de SMPC que cursa con aumento de células precursoras eritroides, aunque también cursa con aumento de células granulocíticas y de megacariocitos. Este aumento de todas las estirpes celulares se denomina panmielosis. La gran elevación de eritrocitos conlleva a una disminución de la eritropoyetina. Es un poco más frecuente en varones con mayor frecuencia entre los 50 a 70 años.
Desconocida, aunque está asociada a la mutación V617F del gen JAK2 o del exón 12.
Se observa 3 fases clínicas:
Fase prepolicitémica: cursa asintomática o a veces con algunos síntomas.
Fase policitémica: cursa sintomática
Fase gastada: se caracteriza por la fibrosis en médula ósea que conlleva a hipocelularidad de esta como consecuencia clínica de pancitopenia. Los síntomas incluyen fiebre, sudoración, baja de peso, hipertensión arterial, úlcera péptica, prurito, plétora, cianosis, eritromelalgia. Clínica por hiperviscosidad como cefalea, parestesias en extremidades, vértigo, astenia, falta de concentración y eventos trombóticos sobre todo venosos. Es importante también la gran esplenomegalia con la que cursan. Cuando llegan a la fase gastada cursan típicamente con visceromegalia importante, asociado a signos de citopenias.
Criterios diagnósticos
Criterios mayores:
Hemoglobina más de 16.5 g/dl en varones y más de 16 g/dl en mujeres
♦ O hematocrito mayor a 49% en varones y > 48% en mujeres
♦ O aumento de la masa de eritrocitos en más del 25% del valor normal
Biopsia de médula ósea con panmielosis
Mutación V617F del gen JAK2 o del exón 12
Criterio menor:
Eritropoyetina disminuida
El diagnóstico se realiza con tres criterios mayores o dos mayores más un menor.
Las opciones terapéuticas son flebotomías, ácido acetilsalicílico e hidroxiuria.
Es un tipo de SMPC que se presenta con mayor frecuencia en personas de edad media con igual prevalencia en mujeres y varones.
Etiología
Es de causa idiopática, aunque se asocia a otras neoplasias, tuberculosis, enfermedad de Paget.
Clínica

Cursa con tres fases clínicas:
Mielofibrosis: cursara con signos de anemia, plaquetopenia y leucopenia, ósea como una insuficiencia medular.
Metaplasia mieloide: cursa con una hematopoyesis extramedular con gran esplenomegalia y hepatomegalia, anemia por secuestro con leucocitosis e incluso células blásticas en sangre periférica y trombocitosis con plaquetas disfuncionales. Los eritrocitos tienen forma de lágrima (Dacriocitos)

Osteoesclerosis: cursa con dolor óseo y aumento de la densidad radiológica.
Exámenes
Fibrosis en médula ósea y en aspirado de médula ósea se ve “aspirado seco”
Mutación V617F del gen JAK2 (presente en el 50% de casos)
Muestra de médula ósea de un paciente con mielofibrosis idopática, nótese el gran componente de fibrosis
Manejo
En pacientes asintomáticos el manejo es observación, pero cuando son sintomáticos las opciones terapéuticas son:
TPH como tratamiento curativo
Hidroxiuria, este es la quimioterapia de elección. Anagrelida, para la trombocitosis intensa.
Es un tipo de SMPC caracterizado por una hiperplasia megacariocítica en médula ósea, por ende, un gran aumento de plaquetas, pero disfuncionales, dismórficas y grandes en sangre. Suele ser más frecuente entre la quinta a octava década de la vida y de mayor prevalencia en mujeres.
Etiología
Desconocida.
Clínica

La mayoría son asintomáticos, aunque si hacen clínica pueden presentarse con signos de sangrado, ya que, si bien las plaquetas están aumentadas, estas son disfuncionales. Además, también pueden presentarse con trombosis arterial y venosa. La esplenomegalia no es característica de estos pacientes, sino por el contrario debido a los infartos embólicos llevan a atrofia del bazo.
Exámenes
Trombocitosis mayor a 1 millón de plaquetas
Mutación V617F del gen JAK2 (presente en el 50 a 60% de casos)
Figura 40. Lámina periférica de un paciente con trombocitosis esencial, nótese el gran número de plaquetas
Manejo
No tiene tratamiento específico. En los asintomáticos se haría observación, pero si son sintomáticos podría usarse:
Trasplante de progenitores hematopoyéticos (TPH), como tratamiento curativo Hidroxiuria, es la terapia más utilizada.
Ácido acteilsalicílico, si hay síntomas de microoclusión vascular Anagrelida, para manejar las grandes cifras de plaquetas.

Los linfomas son neoplasias hematológicas que se inician fuera de la médula ósea, los linfomas de Hodgkin son aquellos que nacen en los ganglios. Son neoplasias más frecuentes en varones con un doble pico de mayor presentación entre la segunda a tercera década de la vida y en la sexta década de la vida. Lo más frecuente es que deriven de linfocitos tipo B.
Es de etiología desconocida, aunque se asocia al VEB, VIH.
Esclerosis nodular: es el tipo más frecuente con un rango de 40 a 80% de los casos. Se suele presentar en mujeres jóvenes, se caracteriza por la afectación de mediastino. Su signo anatomopatológico es la célula lacunar. Es el segundo de mejor pronóstico.
Celularidad mixta: es el segundo tipo más frecuente con 20 a 40% de los casos. Se presenta en varones y adultos mayores. Afecta generalmente ganglios abdominales. Es el tercero con mejor pronóstico. Predominio linfoide: ocupa el tercer lugar en frecuencia con 2 a 10% de los casos. Es de varones jóvenes. En su anatomopatología se encuentra células en palomita de maíz. Es el que tiene el mejor pronóstico. Su afectación suele ser localizada.
Depleción linfoide: es el tipo más raro, ocupando el cuarto lugar en frecuencia. Se presenta en varones, ancianos y en pacientes con VIH. Es el que tiene el peor pronóstico. Su afectación suele ser diseminada.
El órgano linfoide que contiene los corpúsculos de Hassall es el timo.
(ESSALUD 2012)
Exámenes
La clínica inicial suele ser la presencia de adenopatía cervical (lo más frecuente) o en mediastino. Signo de Hoster (dolor en ganglio con el consumo de alcohol) .
Síntomas tipo B: fiebre, cansancio, baja de peso, sudoración .
Hemograma: leucocitosis con eosinofilia para luego cursar con linfopenia, no hay leucemización. Es característico la elevación de la VSG Imágenes, se solicitan para ver la extensión de linfoma, como TEM, RMN, gammagrafía y PET. Anatomopatología, se realiza la biopsia ganglionar donde la célula característica es la célula de Reed-Sternberg.

El estadiaje se realiza según el estadiaje de Ann-Arbor:
Estadio I: afectación de una única región ganglionar
Estadio II: Afectación de 2 o más regiones ganglionares a un mismo lado del diafragma (ESSALUD 2003)
Estadio III: afectación ganglionar a ambos lados del diafragma
Estadio IV: afectación extranodal que no contiguos y/o de médula ósea.
Sufijos:
E: si la afección es por contiguidad
X: enfermedad voluminosa (bulky), más de 10 cm.
A: Sin síntomas
B: Con síntomas generales
Los tipos I y II son los localizados, los tipos III y IV son los avanzados.
Localizado: quimioterapia con ABVD más radioterapia

Avanzados o sintomáticos: quimioterapia con ABVD o BEACOPP
En pacientes con recidiva: quimioterapia más autotransplante de células hematopoyéticas.
FACTOR 0 1
Edad <45 años >45 años
Sexo Femenino Masculino
Estadio I, II y III IV
Albúmina >4g/dL <4g/dL
Lecucocitos <15mil/mm3 >15mil/mm3

Linfocitos >600/mm3(>8%) <600/mm3(<8%)
Con 0 puntos hay una supervivencia del 80% y con 5 puntos hay una supervivencia de 45% aproximadamente.
Los linfomas son neoplasias hematológicas que nacen en un lugar diferente a la médula ósea. Serán No Hodgkin porque tienen un comportamiento diferente al Hodgkin, es decir, suelen nacer en órganos o ganglios. Son más frecuentes que el linfoma de Hodgkin. Son más frecuentes en varones y en edad media.
Desconocida, aunque se relaciona con inmunodepresión, radioterapia, quimioterapia, VEB, HTLV, VIH y H. pylori.
Indolentes o de baja agresividad
Linfomas foliculares: Son los más frecuentes a nivel mundial.
Linfoma linfocítico de células pequeñas
Linfomas MALT: más frecuente en estómago y asociado a Helicobacter pylori.
Linfomas de células T: Micosis fungoide (ESSALUD 2002, 2015)
Alta agresividad
Linfomas de células del Manto
Linfoma difuso de células grandes B: el más frecuente en el mundo occidental.
Linfoma linfoblástico
Linfoma relacionado con el SIDA: típicamente en cerebro.
Linfoma de Burkit: está relacionado al VEB.
El linfoma de Hodgkin extraganglionar más frecuente es en estómago.
Clínica
La mayoría de los pacientes (aproximadamente el 80%) acude con una enfermedad avanzada. Cursan con una alteración de su inmunidad parecido a la LCL.
Al examen físico se evidencia adenopatías en cualquier zona, pero a predominio periférico, siendo infrecuente el compromiso ganglionar en mediastino. Los síntomas generales son infrecuentes en estos pacientes. Por otro lado, su compromiso de órganos extraganglionares es muy frecuente, como por ejemplo en tracto gastrointestinal y en SNC.
La diseminación de las células neoplásicas es por vía hematógena.
Tratamiento
Baja agresividad
Asintomático o no avanzado: observación o radioterapia con o sin quimioterapia
Avanzado: quimioterapia más rituximab
Alta agresividad
Quimioterapia más rituximab

O trasplante de progenitores hematopoyéticos
El rituximab se usa en aquellos que derivan de linfocitos tipo B.
Factor 0 1
Edad < 60 años >60 años
Estadio I y II III y IV
Desempeño Bueno Malo
Localización extraganglionar <2 sitios >2 sitios
LDH Normal Elevado
Tabla 26. Índice pronóstico internacional para linfoma no Hodgkin
Puntaje de 0 a 1: bajo riesgo; puntaje de 2 a 3: riesgo intermedio; y puntaje de 4 a 5: riesgo elevado.
Las gammapatías monoclonales son un tipo de neoplasias por proliferación de un clon de linfocito B o plasmocito los cuales producen inmunoglobulinas, también llamado componente M o proteína M. Esta proteína M puede ser un anticuerpo intacto, un anticuerpo alterado o un fragmento de este.
Es un tipo de gammapatía monoclonal o también llamado plasmocitopatía. También llamado como enfermedad de Kahler. Se trata de una proliferación de células plasmáticas. Suele presentarse en pacientes varones mayores de 60 años y principalmente en etnia afroamericana.
El mieloma múltiple es la neoplasia de células plasmáticas más frecuente.
La excreción renal de la proteína de Bence Jones es la causa más frecuente de insuficiencia renal en pacientes con mieloma múltiple.
Desconocida.
Fisiopatología y clínica
Osteolisis: por la infiltración de hueso.
Dolor óseo: es el síntoma más frecuente. Los dolores suelen ser en espalda y costillas al movimiento.
Fracturas
Hipercalcemia: con clínica de hipercalcemia, calcio elevado en orina, nefritis intersticial e insuficiencia renal.
Paraproteinemia monoclonal: los anticuerpos más producidos en orden son: IgG (55-60%), IgA (25%), IgD (1%), IgE(raro) e IgM.
Síndrome de hiperviscosidad
Alteración plaquetaria: cursará con signos de sangrado
Excreción renal de la proteína de Bence Jones lo que llevará a insuficiencia renal Mieloptisis por células plasmáticas.
Anemia
Pancitopenia
Inmunodepresión lo que predispone a infecciones.
Proteinograma electroforética con pico monoclonal
Hemograma con anemia
Lámina periférica con hematíes en pila de moneda (Roleaux)
Otros: VSG, hiperproteinemia, hipercalcemia.
Radiografía con lesiones osteolíticas (signo de sacabocados en radiografía de cráneo)
Aspirado de médula ósea con células plasmáticas monoclonales en >10%
Tratamiento
Asintomáticos, sin daño de órgano o mieloma quiescente: observación.
Sintomático o daño de órgano: quimioterapia (Melfalan, Alkeran) (ESSALUD 2002) más autotransplante de células progenitores hematopoyéticos.

Pronóstico
Infecciones: actualmente es la causa más frecuente de mortalidad
Insuficiencia renal: paso a un segundo lugar como causa de mortalidad

Es una complicación que suele presentarse en el curso de las neoplasias y típicamente en las neoplasias hematológicas, y también se presenta secundaria al tratamiento antineoplásico. Consiste en la lisis de las células tumorales y liberación del contenido de dichas células.
Espontáneas
Post tratamiento antineoplásico
Al romperse espontáneamente o por el tratamiento, las células neoplásicas liberan su contenido. El material genético al metabolizarse produce ácido úrico y libera fósforo, lo que conlleva a una hiperuricemia e hiperfosfatemia. El fósforo empieza a precipitar al calcio lo que conlleva a hipocalcemia. Por otro lado, recordemos que dentro del citoplasma hay gran contenido de potasio y al romperse la célula tumoral libera este electrolito con la consecuente hiperpotasemia.
Criterios de síndrome de lisis tumoral analítico
Mayor o igual a dos de los siguientes en los 3 días antes o 7 días posteriores al tratamiento:
Ácido úrico $8mg/dl o ↑25% del basal
Potasio $6mEq/L o ↑25% del basal
Fósforo $2.1mcmol/L o $6.5mg/dl en niños o $4.5mg/dl en adultos o ↑25% del basal
Calcio #1.75mcmol/L o #7mg/dl o ↓25% del basal
Criterios de síndrome de lisis tumoral clínico
Síndrome de lisis tumoral analítico y 1 o más de los siguientes:
Creatinina >1.5 veces del límite superior de la normalidad
Arritmia
Convulsiones
Muerte súbita
El manejo se basa en la prevención y depende de la carga tumoral y el riesgo de lisis que eso genera. Sería de la siguiente manera:
Carga tumoral y riesgo de lisis Lab SLT: 1 Alt. Lab SLT: $2 Alt. Lab SLT + $1 de los sgtes:
- Cr $1.5LSN
- Arritmia
- Convulsiones
Mediano Grande Pequeño
Riesgo Min. R No profilax.
Riesgo
Riesgo o incierrto
Disfx renal/hpa/Ac.
Riesgo
- Profilaxis
Clínico SLT
Riesgo - Hidratación
- Rasburicarse
- Monit. cardiaca
- Lab c/6-8h
Riesgo
- Hidratación
- Alopurinol o rasburicarse
- Lab c/8-12h
- Hidratación +/- alopurinol

- Monit. cercano
- Hidratación
- Rasburicarse
- Monit. cardiaca/UCI
- Lab c/4-6h
En los pacientes que reciben terapia antineoplásica puede afectarse la mielopoyesis conllevando a una neutropenia y alteración de las defensas del organismo; es así que el paciente se predispone a infecciones, siendo la fiebre el único indicador de infección.
El valor absoluto de los neutrófilos es la sumatoria de segmentados más bastones. . Los neutrófilos son fagocitos primarios en sangre periférica.. Neutrofilia se define como > 7500 neutrófilos/ mm3.
(ESSALUD 2009)
Fiebre: Según la Sociedad Estadounidense de Enfermedades Infecciosas, la fiebre en pacientes neutropénicos se define como una temperatura oral única de ≥38,3 ° C (101 ° F) o una temperatura de ≥38,0 ° C (100,4 ° F) sostenida durante un período de una hora.
Neutropenia: se define cuando el nivel de neutrófilos es menor de 1500 células/ mm3, también se clasifica en grados:
Neutropenia leve: 1000 a 1500 células/mm3
Neutropenia moderada: 500 a 1500 células/mm3
Neutropenia severa: menor a 500 células/mm3
Síndrome de fiebre neutropénica: La sociedad internacional de imunodepresión (ICHS) ha clasificado los síndromes de fiebre neutropénica inicial en las siguientes tres categorías:
Infección documentada microbiológicamente: fiebre neutropénica con un foco clínico de infección y un patógeno asociado.
Infección clínicamente documentada: fiebre neutropénica con un foco clínico (por ejemplo, celulitis, neumonía) pero sin el aislamiento de un patógeno asociado Fiebre inexplicable: fiebre neutropénica sin un foco clínico de infección ni un patógeno identificado
La evaluación clínica inicial se centra en evaluar el riesgo de complicaciones graves. Esta evaluación de riesgos dicta el enfoque de la terapia, incluida la necesidad de hospitalización, antibióticos intravenosos y hospitalización prolongada.
Se considera que los pacientes con cualquiera de las siguientes características tienen un alto riesgo de sufrir complicaciones graves durante los episodios de fiebre neutropénica: Recepción de terapia citotóxica suficientemente mielosupresora como para provocar neutropenia grave anticipada (Neutrófilos <500 células/mm3) durante> 7 días
Puntuación del índice de riesgo MASCC <21
Puntuación CISNE de ≥3 (en pacientes con tumores sólidos)
Presencia de cualquier problema médico comórbido activo no controlado, que incluye, entre otros:
♦ Signos de sepsis grave o shock séptico (por ejemplo, inestabilidad hemodinámica, cambios en el estado mental de nueva aparición, disfunción respiratoria, oliguria)
♦ Mucositis oral o gastrointestinal que interfiere con la deglución o causa diarrea severa.
♦ Síntomas gastrointestinales, que incluyen dolor abdominal, náuseas y vómitos o diarrea.
♦ Infección del catéter intravascular, especialmente infección del túnel del catéter.
♦ Nuevo infiltrado pulmonar o hipoxemia.
♦ Enfermedad pulmonar crónica subyacente
♦ Infección compleja en el momento de la presentación.
Uso de alemtuzumab o células CAR-T (células T con receptores quiméricos antigénicos) en los últimos dos meses
Cáncer incontrolado o progresivo
Evidencia de insuficiencia hepática (definida como niveles de aminotransferasas > 5 veces los valores normales) o insuficiencia renal (definida como un aclaramiento de creatinina <30 ml / minuto).
Carga de la enfermedad Puntaje
Sin síntomas o síntomas leves
5 puntos
Síntomas moderados 3 puntos
Síntomas severos 0 puntos
Comorbilidades
Puntaje
Sin hipotensión 5 puntos
Sin enfermedad pulmonar obstructiva crónica 4 puntos
Tumor sólido o neoplasia maligna hematológica sin antecedentes de infecciones fúngicas previas
4 puntos
Sin deshidratación que requiera fluidos parenterales 3 puntos
Estado Puntaje
Estado ambulatorio en el momento del inicio del síndrome de fiebre neutropénica
3 puntos
Edad Puntaje
Menos de 60 años
Mayor o igual a 60 años
Puntaje MASCC:
2 puntos
0 puntos
21 a 26 puntos: Pacientes con bajo riesgo de complicaciones médicas y aquellos para quienes el manejo ambulatorio con un régimen antibacteriano empírico oral puede ser seguro y efectivo.
0 a 20 puntos: Pacientes con alto riesgo de complicaciones médicas. Los pacientes de alto riesgo requieren hospitalización para recibir antibióticos por vía intravenosa y, a menudo, requieren una hospitalización prolongada.

¿El paciente tiene alto riesgo de complicaciones médicas?
¿El paciente tiene alguno de las siguientes que requiera admisión a hospitalización?

- No pueden tomar o absorber los antibióticos por vía oral o mucositis gastrointestinal o nauseas
- No tiene cuidador
- No tiene teléfono
- Imposibilidad de acudir rápidamente a un centro de atención
Admitir al paciente al hospital para iniciar terapia antibiótica empírica endovenosa
Administrar vía oral amoxicilina+ácido clavulánico con ciprofloxacino y observarlo por $4 horas antes de darle de alta
Sangre total Paquete de glóbulos rojos Concentrado de plaquetas
Albumina Globulinas
La dosis de transfusión de hematíes en niños es 10 a 20 cc/kg/ dosis

Reacciones adversas inmediatas inmunológicas:
Plasma fresco congelado Crioprecipitado
Concentración de factores de coagulación
Reacciones hemolíticas: Son debidas a la administración de sangre incompatible. Es la primera causa de muerte asociada a la transfusión de sangre.
Reacción febril no hemolítica: Es la reacción adversa más frecuente, es debido a la presencia de anticuerpos antileucocitarios y/o antiplaquetarios.
Reacción anafiláctica: Reacción alérgica severa debido a la presencia de anticuerpos antiIgA, que puede desencadenar un estado de shock.
Urticaria: Reacción alérgica leve contra algunas proteínas plasmáticas; es la segunda reacción adversa más frecuente.
Daño pulmonar agudo asociado a la transfusión «TRALI»: Ocasionada por la presencia de anticuerpos antileucocitarios que forman agregados a nivel de la microcirculación pulmonar. Es la segunda causa de muerte asociada a la transfusión de sangre.
Insuficiencia cardiaca congestiva: Es originada por la sobrecarga circulatoria en pacientes con alteraciones previas en su función cardiovascular, pulmonar y/o edad avanzada.
Sepsis: Ocasionada por contaminación bacteriana de la transfusión.

Hemólisis no inmune: Es la destrucción de hematíes por efecto mecánico- traumático, efecto de temperatura (congelación ó sobrecalentamiento), efecto osmótico (infusión simultánea de soluciones no isotónicas), drogas, etc.
Hipotensión por inhibidor de la ECA.
Embolia: Actualmente poco frecuente por el uso de bolsa y filtros, es debida a la presencia de aire o microtrombos en la sangre almacenada.
Reacciones adversas tardías inmunológicas:
Hemólisis retardada: Debido a la presencia y reacción de anticuerpos anamnésicos, producto de sensibilizaciones anteriores.
Enfermedad de rechazo «injerto – huésped»: Ocasionada por la transfusión de linfocitos «contaminantes» e inmunocompetentes que lesionan tejidos del receptor.
Púrpura trombocitopénica post-transfusional: Púrpura generalizada por plaquetopenia, debida a su vez a la presencia de anticuerpos antiplaquetarios.
Aloinmunizaciones: Ocasionada por la exposición del receptor a antígenos «extraños» del donante, formando anticuerpos irregulares, que podrían ocasionar problemas de incompatibilidad en futuras transfusiones.
Inmunomodulación: La transfusión sanguínea tendría un efecto inmunomodulatorio en lo referente a evolución de cáncer, respuesta a infecciones, etc.
Reacciones adversas tardías no inmunológicas:
Trasmisión de enfermedades infecciosas: Ocasionadas por el pasaje en la sangre de agentes infecciosos virales, bacterianos y/o parasitarios.
Hemosiderosis